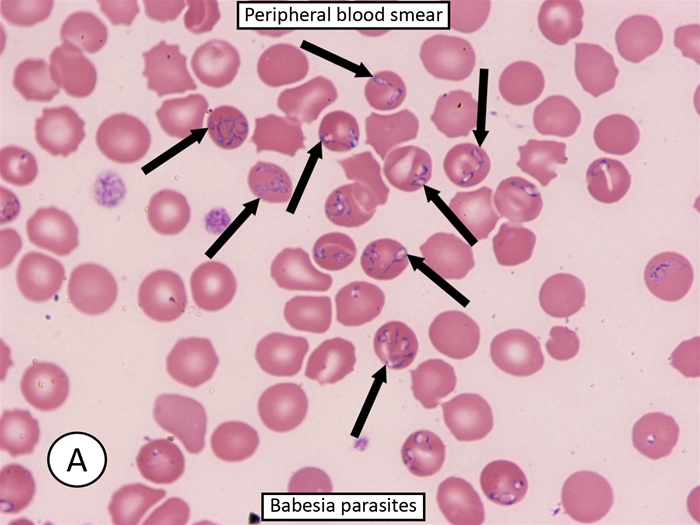
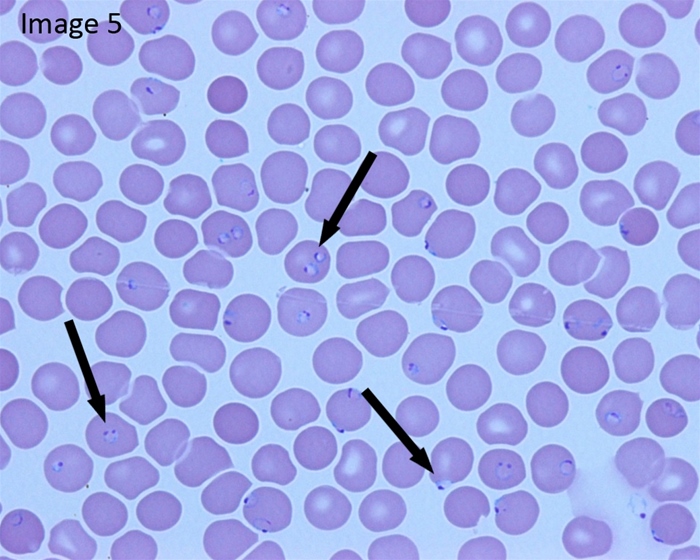

Step 2 Uworld 1
Study Designs

Cohort: compares incidence and calculate relative risks
Case control: compares exposures to risk factor and calculate odds ratio
Case series: A case series can be helpful in determining the natural history of uncommon conditions, but it provides no information about disease incidence.
Clinic trials: A clinical trial compares the therapeutic benefit of interventions
Traumatic Amputations
All patients suffering traumatic amputations should be treated as candidates for reimplantation while in the field. As such, their amputated limb or digit should be wrapped in sterile gauze, moistened with sterile saline and placed in a plastic bag. The bag should be then placed on ice and transported with the patient to the nearest emergency department. The amputated part should not be allowed to freeze. Packaging of the amputated part in this manner prolongs the viability of the part for up to 24 hours. Younger patients suffering sharp amputations with no crush injury or avulsion are the best candidates for amputation reimplantation.
In water: damages vessels
In antiseptic/alcohol: chemical injury
Ice directly: frostbite
DVT
10a inhibitors: 2-5 hours onset, no overlap, no lab monitoring needed
Warfarin: 5-7 days onset
Thrombolytic therapy is typically reserved for hemodynamically unstable patients with PE. Less commonly, it is used for massive proximal DVT associated with significant symptomatic swelling and/or limb ischemia. It is not indicated in this patient with moderate pretibial edema and absence of hypotension and tachycardia.
Anticoagulation failure (eg, recurrent or extending thromboembolism while fully anticoagulated) or anticoagulation contraindication (eg, active bleeding) are indications for inferior vena cava filter placement. This patient is not considered to have anticoagulation failure as his INR is grossly subtherapeutic (he is not fully anticoagulated).
Sexual behavior in kids
Sexual behavior in preadolescents
Normal
Abnormal for both
Toddler Exploring one's own or others' genitals Masturbatory movements Undressing self or others
Repeated insertion of objects into vagina or anus Sex play involving genital-genital, oral-genital, or anal-genital contact Use of force, threats, or bribes in sex play Age-inappropriate sexual knowledge
School-age Increased interest in sex words & play Asking questions about sex & reproduction Masturbatory movements (may become more sophisticated)
Young children are naturally curious about their bodies, and it is developmentally normal for toddlers and preschoolers to touch their own or other young children's genitals (Choice G). Occasional genital self-stimulation is also common (Choice B), as is asking about reproduction, playing "doctor" with other children, dressing in the typical clothing of the other gender, and attempting to undress themselves or others. These behaviors are usually brief and distractible and should not be stigmatized but rather redirected if socially inappropriate (ie, self-stimulation in public). These behaviors typically decrease as children approach adolescence, when they become more aware of social norms and expectations and have an increased need for privacy.
There are, however, sexual behaviors that are of concern in young children, such as precocious sexual knowledge, preoccupation with masturbation, excessive or aggressive talk about sexuality, and simulating genital-genital, oral-genital, or anal-genital contact. The reports by this patient's mother about his simulation of oral sex using dolls should be explored further. Knowledge about the specific details of sexual acts would be of concern in a 4-year-old. Anogenital trauma, coercive sex play, or repeated urinary tract infections with no medical cause should also raise concerns about possible sexual abuse.
Cyclic Vomiting Syndrome

This child has a recurrent, predictable pattern of acute and frequent vomiting that resolves spontaneously with no symptoms in between episodes. This patient's growth, eating patterns, and diagnostic tests are also normal. In the context of a family history of migraines, these findings suggest cyclic vomiting syndrome (CVS).
The incidence of CVS is highest in children whose parents have a history of migraine headaches. The etiology of CVS is unclear, but it is thought to be linked to abdominal migraine, which generally presents with abdominal pain as the primary symptom. Some children progress from CVS to abdominal migraines and migraine headaches.
Complications that may arise from recurrent vomiting include anemia and dehydration. Treatment consists of hydration, antiemetics (eg, ondansetron), and reassurance of the parents. Children with a family history of migraines are likely to benefit from anti-migraine therapy such as sumatriptan. Approximately 2/3 children with CVS have gradual resolution of their symptoms in 5–10 years.
Digital Clubbing

Digital clubbing describes bulbous enlargement and broadening of the fingertips due to connective tissue proliferation at the nail bed and distal phalanx. It is diagnosed when the angle between the nail fold and the nail plate is >180° (Lovibond angle). Clubbing can occur by itself or associated with hypertrophic osteoarthropathy, which presents with painful joint enlargement, periostosis of long bones, and synovial effusions. Clubbing may be hereditary, but is most often due to pulmonary or cardiovascular diseases. The most common causes of secondary clubbing are lung malignancies, cystic fibrosis, and right-to-left cardiac shunts.
COPD, PHTN, and hypoxemia alone cannot cause clubbing.
Pathophysiology involves megakaryocytes that skip the normal route of fragmentation within pulmonary circulation (due to circulatory disruption from tumors, chronic lung inflammation) to enter systemic circulation. Megakaryocytes become entrapped in the distal fingertips due to their large size and release platelet-derived growth factor (PDGF) and vascular endothelial growth factor (VEGF). PDGF and VEGF have growth-promoting properties that increase connective tissue hypertrophy and capillary permeability and vascularity, ultimately leading to clubbing.
GBS respiratory
Once GBS is suspected in a hemodynamically stable patient, the next step in management is to assess pulmonary function with spirometry. Forced vital capacity (FVC) and negative inspiratory force monitor respiratory muscle strength, and serial pulmonary function testing should be performed given the potential for rapid progression of disease. A decline in FVC (≤20 mL/kg) indicates impending respiratory failure warranting endotracheal intubation. Additional indications for elective or emergency intubation include respiratory distress (eg, tachypnea, accessory muscle use), severe dysautonomia (eg, heart rate and blood pressure instability), or widened pulse pressure. With early diagnosis and cardiopulmonary monitoring and support, most young patients experience spontaneous recovery.
Toddler development
Developmental milestones during first year of life
Age (months)
Gross Motor
Fine Motor
Language
Social/cognitive
2
Lifts head/chest in prone position
Hands unfisted 50% of the time Tracks past midline
Alerts to voice/sound Coos
Social smile Recognizes parents
4
Sits with trunk support Begins rolling
Hands mostly open Reaches midline
Laughs Turns to voice
Enjoys looking around
6
Sits momentarily propped on hands (unsupported by 7 months)
Transfers objects hand to hand Raking grasp
Responds to name Babbles
Stranger anxiety
9
Pulls to stand Cruises
3-finger pincer grasp Holds bottle or cup
Says "dada," "mama"
Waves "bye" Plays "pat-a-cake"
12
Stands well Walks first steps independently Throws ball
2-finger pincer grasp
Says first words other than "dada," "mama"
Separation anxiety Comes when called
Routine well-child visits are an opportunity to assess growth and development, as delays can signify a serious medical problem. Infants grow rapidly during the first 6 months of life, gaining approximately 1 oz (30 g) a day for the first 3 months and doubling their birth weight by age 4 months. By age 12 months, an infant's weightshould triple and height should increase by 50%, as seen in this patient.
At age 12 months, an infant should stand well and walk with support. First independent steps often occur around age 12 months and should be present by no later than 15 months in normal development. A 12-month-old infant typically uses a 2-finger pincer grasp (ie, thumb and first finger) to pick up objects and eat table foods, as seen in this patient. Saying at least 1 word other than "mama" and "dada" is typical language development at this age, and an infant should also be able to follow a 1-step command (eg, come when called) accompanied by a gesture.
Although this infant may not demonstrate full language abilities at the physician's office due to shyness in an unfamiliar environment, his reported language development is age-appropriate. This patient also exhibits normal motor milestones and will likely begin walking independently within the next few months. The parents should be reassured that their son is growing and developing normally.
Developmental milestones during toddlerhood
Age
Gross motor
Fine motor
Language
Social/Cognitive
12 months
Stands well Walks first steps independently Throws a ball
2-finger pincer grasp
Says first words (other than “mama” & “dada”)
Separation anxiety Follows 1-step commands with gestures
18 months
Runs Kicks a ball
Builds a tower of 2-4 cubes Removes clothing
10- to 25-word vocabulary Identifies ≥1 body parts
Understands “mine” Begins pretend play
2 years
Walks up/down stairs with both feet on each step Jumps
Builds a tower of 6 cubes Copies a line
Vocabulary ≥50 words 2-word phrases
Follows 2-step commands Parallel play Begins toilet training
3 years
Walks up/down stairs with alternating feet Rides tricycle
Copies a circle Uses utensils
3-word sentences Speech 75% intelligible
Knows age/gender Imaginative play
4 years
Balances & hops on 1 foot
Copies a cross
Identifies colors Speech 100% intelligible
Cooperative play
5 years
Skips Catches ball with 2 hands
Copies a squareTies shoelaces Dresses/bathes independently Prints letters
Counts to 105-word sentences
Has friends Completes toilet training
Pseudotumor cerebri
Treatment goals for IIH are prevention of vision loss, reduction of intracranial pressure, and symptomatic relief of headaches. Funduscopy and routine monitoring of visual acuity and visual fields are required to prevent vision loss. IIH can be caused by certain medications (eg, tetracyclines, isotretinoin), which should be avoided in this patient population. Weight loss may help with resolution of symptoms. Acetazolamide is the first-line medical treatment for IIH. It inhibits choroid plexus carbonic anhydrase, thereby decreasing CSF production and IH. Furosemide can be added for patients with continued symptoms on acetazolamide.
For patients with symptoms refractory to medical therapy or those with progressive vision loss, surgical intervention with optic nerve sheath decompression or lumboperitoneal shunting is recommended (Choice E). Short-term use of corticosteroids or serial lumbar puncture (LP) can serve as bridging therapy for patients awaiting definitive surgical treatment (Choice C). These are not recommended as primary intervention due to side effects associated with long-term corticosteroid use and the complications associated with LPs.
Myasthenic Crisis

This patient with myasthenia gravis (MG) is most likely suffering from myasthenic crisis, characterized by severe respiratory muscle weakness leading to respiratory failure. Individuals often have increasing generalized and bulbar muscle weakness (eg, difficulty coughing up sputum) prior to the onset of crisis. The condition may be precipitated by infection (eg, pneumonia), surgery, or various medications (eg, azithromycin).
Patients with deteriorating respiratory status (eg, declining oxygen saturation and vital capacity) should first be intubated for airway protection. Following intubation, acetylcholinesterase inhibitors (eg, pyridostigmine) used in the daily management of MG are temporarily held to reduce excess airway secretions and the risk of aspiration.
Once stabilized, patients in myasthenic crisis require treatment with intravenous immunoglobulins or plasmapheresis (preferred) in addition to corticosteroids. Other immunomodulatory therapy (eg, mycophenolate mofetil or azathioprine) can be considered, especially if corticosteroid therapy is ineffective, but usually requires several weeks to reach clinical efficacy.
Heat Stroke

When ice water immersion is not readily available or is difficult (eg, lack of equipment/staff, need for intubation), other cooling techniques, such as continual high-flow dousing with cold water, cold water shower, gastric lavage with cool water, or evaporative cooling (ie, spraying the naked patient with lukewarm water and running fans to circulate air), may be considered. These appear to be less effective than ice water immersion. Evaporative cooling is preferred for nonexertional or classic heat stroke (seen in elderly patients with underlying comorbidities that limit their ability to cope with excessive heat) as ice water immersion is associated with higher morbidity and mortality in these patients.
Mitral Stenosis

This patient's left-sided hemiparesis is likely due to thromboembolic stroke from atrial fibrillation in the setting of mitral stenosis (MS).
In a young patient from a developing country, the clinical presentation of progressive dyspnea, nocturnal cough, and hemoptysis is highly suggestive of rheumatic MS. Long-standing MS leads to an increase in left atrial pressure, which in turn leads to elevated pulmonary pressures and pulmonary vascular congestion; these changes can cause dyspnea, orthopnea, paroxysmal nocturnal dyspnea, and hemoptysis.
In addition, the left atrial enlargement resulting from increased left atrial pressure predisposes to the development of atrial fibrillation (eg, palpitations, irregular heartbeat), which increases the risk of left atrial thrombus formation and systemic thromboembolic complications (eg, stroke).
Abnormal flow volume loop
Pulmonary edema, pneumothorax:

Asthma:

Laryngeal edema:

Panic attack: normal
Infectious Mono
Infectious mononucleosis commonly presents with prolonged fever, sore throat, malaise, and jaundice. Physical findings include enlarged, erythematous tonsils with exudates, hepatosplenomegaly, and lymphadenopathy (commonly cervical but may be generalized). The etiologic agent is usually Epstein-Barr virus (EBV). Laboratory findings can include decreased leukocytes due to viral suppression, positive antiheterophile antibodies in the serum (monospot test), and atypical lymphocytes on blood smear.
Rare but dangerous complications of infectious mononucleosis include splenic rupture, airway compromise, and autoimmune hemolytic anemia and thrombocytopenia. Anemia and thrombocytopenia are a result of the cross-reactivity of EBV-induced antibodies against red blood cells and platelets. These antibodies are IgM cold-agglutinin antibodies that cause complement-mediated destruction of red blood cells. Hemolysis likely explains the elevations in bilirubin and transaminase levels seen in this patient. Coombs test is generally positive, and reticulocyte count is elevated (also seen in this patient). The onset of the hemolytic anemia can be 2-3 weeks after the onset of symptoms.
Constrictive Pericarditis

The most likely diagnosis in this patient is constrictive pericarditis, a condition marked by pericardial fibrosis and obliteration of the pericardial space. Constrictive pericarditis impairs ventricular filling during diastole, causing patients to experience symptoms related to decreased cardiac output (fatigue and dyspnea on exertion) and signs of venous overload (elevated JVP, ascites, and pedal edema). Kussmaul's sign, defined as lack of the typical inspiratory decline in central venous pressure, and the presence of a pericardial knock (early heart sound after S2) may also be seen. Sharp x and y descents are characteristically seen on central venous tracing. Pericardial calcifications can sometimes be seen on chest x-ray and, when present, help confirm the diagnosis.
In developing countries and endemic areas (eg, Africa, India & China), tuberculosis is a common cause of constrictive pericarditis. In the United States, the most common causes include idiopathic or viral pericarditis (>40%), radiation therapy (30%), cardiac surgery (10%), and connective tissue disorders.
Perivalvular Abscess
On physical examination, this patient shows evidence of intravenous drug use (needle track marks) and aortic regurgitation (early diastolic murmur). When aortic regurgitation (AR) is due to valvular disease, the early diastolic murmur is best heard along the left sternal border (3rd and 4th intercostal spaces). However, when the AR murmur is due to aortic root disease, it is best heard along the right sternal border. In this patient, the electrocardiogram (ECG) shows evidence of conduction abnormality with 2:1 second-degree atrioventricular (AV) block. These features are suggestive of aortic valve endocarditis complicated by a perivalvular abscess and resulting AV conduction block and syncope.
Perivalvular abscess is seen in approximately 30%-40% of patients with infective endocarditis at the time of surgery or autopsy. The development of a new conduction abnormality in patients with infective endocarditis should raise suspicion for a perivalvular abscess extending into the adjacent cardiac conduction pathways. Aside from aortic valve involvement, intravenous drug abuse is also an independent predictor of periannular extension of infection.
However, tricuspid endocarditis usually presents with a systolic murmur (holosystolic murmur of tricuspid regurgitation that becomes accentuated with inspiration). Cardiac conduction abnormalities are uncommon in patients with tricuspid valve endocarditis.
Case: drug abuser with episode of syncope, early diastolic murmur at left sternal border with expiration, second degree AV block
Antipsychotic extrapyramidal treatment
Acute dystonia: benztropine, diphenhydramine
Akathisia: add beta blocker
Parkisonism: Amantadine, benztropine
Tardive dyskinesia: valbenazine
Catatonia
This patient's history of severe bipolar disorder and current immobility and mutism are suggestive of catatonia. Catatonia is a syndrome (not a specific disorder) of marked psychomotor disturbance that occurs in severely ill patients with mood disorders with psychotic features, psychotic disorders, autism spectrum disorder, and medical conditions (infectious, metabolic, neurologic, rheumatologic). Common features include decreased motor activity, lack of responsiveness during interview, posturing, and waxy flexibility (initial resistance to repositioning by the examiner, followed by maintenance of new repositioned posture). Catatonia can range from stupor to marked agitation (catatonic excitement), which contributes to difficulty in recognition.
Treatment of catatonia includes benzodiazepines (most commonly lorazepam) and/or electroconvulsive therapy (ECT). A lorazepam challenge test (intravenous lorazepam 1-2 mg) resulting in partial, temporary relief within 5-10 minutes confirms the diagnosis. Catatonia generally responds to lorazepam within a week; ECT is the treatment of choice in patients who do not improve.
Diamond Blackfan
Diamond-Blackfan anemia
Pathogenesis
Congenital erythroid aplasia
Clinical findings
Craniofacial abnormalities Triphalangeal thumbs Increased risk of malignancy
Laboratory findings
Macrocytic anemia Reticulocytopenia Normal platelets, white blood cells
Treatment
Corticosteroids Red blood cell transfusions
This infant has macrocytic anemia, craniofacial anomalies, and triphalangeal thumbs consistent with Diamond-Blackfan anemia (DBA). DBA is caused by a congenital (inherited or sporadic) defect of erythroid progenitor cells, which leads to increased apoptosis of red blood cells, resulting in profound anemia. Most patients have other anomalies, such as short stature, cleft palate, and webbed neck.
DBA typically presents in infancy with progressive pallor and poor feeding due to anemia, as seen in this patient. The heart rate increases to meet oxygen demands, and a faint systolic ejection (flow) murmur may be heard on examination due to increased turbulence across the valves.
Laboratory testing differentiates the type of anemia. In contrast to Fanconi anemia (pancytopenic bone marrow failure), DBA is a pure red cell aplasia with reticulocytopenia and normal platelet and white blood cell counts. Treatment mainly involves corticosteroids or transfusion therapy in refractory cases.
High Cardiac Output
Shunting of a large amount of blood through the fistula decreases systemic vascular resistance, increases cardiac preload, and increases cardiac output. Clinical signs include widened pulse pressure, strong peripheral arterial pulsation (e.g brisk carotid upstroke), systolic flow murmur (as in this patient), tachycardia, and usually flushed extremities. The left ventricle hypertrophies, and the point of maximal impulse is displaced to the left. An ECG usually shows left ventricular hypertrophy.
Pediatric Joint Pain
Infectious
Inflammatory/Rheumatologic
Neoplastic
Onset
Acute
Subacute/chronic
Subacute/chronic
Timing of pain
Constant
Worse in morning
Worse in evening/night
Able to bear weight?
No
Yes
Variable
Multiple joints?
Uncommon
Common
Variable
Laboratory findings
↑ WBC/platelet count ↑ Inflammatory markers
↑ WBC/platelet count, ↓ RBC ↑ Inflammatory markers
↓ WBC/platelet count
This patient presents with chronic oligoarthritis, daily fever, and rash, which is most consistent with a diagnosis of systemic-onset juvenile idiopathic arthritis (sJIA). sJIA is an arthritic auto-inflammatory disease of childhood. Almost all patients with sJIA present with >2 weeks of fever occurring once a day (known as quotidian fever), arthritis of >1 joint, and a pink macular rash that worsens during fever. As with other rheumatologic disorders, the joint pain and stiffness are classically worse in the morning and improve throughout the day. Other clinical findings may include lymphadenopathy and hepatosplenomegaly.
Characteristic laboratory findings include leukocytosis, thrombocytosis, and markedly elevated inflammatory markers (eg, erythrocyte sedimentation rate, C-reactive protein), as well as anemia due to chronic inflammation and/or iron deficiency. The diagnosis can be made clinically once other disorders (eg, leukemia, bacterial arthritis) are ruled out. Treatment includes anti-inflammatory therapies such as nonsteroidal anti-inflammatory drugs, glucocorticoids, or biologic agents.
Biliary Cyst

A biliary cyst (or choledochal cyst) is a congenital dilatation of the biliary tree. These dilatations may be single or multiple and can be intra- or extrahepatic. The most common type of biliary cyst (type I) is a single, extrahepatic cyst. Biliary cysts can be congenital or acquired.
Classic signs of a biliary cyst include abdominal pain, jaundice (due to obstructive cholestasis), and a palpable mass. However, the clinical presentation varies with age. The majority of patients are age <10. Infants can have jaundice and acholic stools, a presentation that resembles biliary atresia. Older children may have pancreatitis. Adults with biliary cysts commonly present with vague epigastric or right upper quadrant abdominal pain or cholangitis. The diagnosis is generally made by ultrasound or other imaging; endoscopic retrograde cholangiopancreatography may be needed if obstruction is suspected. Biliary cysts can transform into cholangiocarcinoma. Surgical resection relieves the obstruction and reduces the risk of malignancy.

Prolactinoma

This patient has a pituitary microadenoma (less than 10 mm) associated with galactorrhea and symptoms of low estrogen (eg, amenorrhea, vaginal dryness). Any mass lesion in the pituitary gland can cause a mild elevation in prolactin due to disruption of the normal inhibitory dopaminergic regulation of prolactin secretion. However, significant elevations in the prolactin level (eg, serum prolactin level more than 200 ng/mL or repeat level >100 ng/mL) suggest a prolactin-secreting tumor (prolactinoma). Elevated prolactin levels suppress gonadotropin-releasing hormone, LH, and estradiol, leading to oligo-amenorrhea in premenopausal females. Men and postmenopausal women often have minimal early symptoms and are more likely to seek evaluation when a large tumor (>1 cm, macroadenoma) causes mass-effect symptoms (eg, headache, visual field defects).
Asymptomatic patients with an incidental finding of a microprolactinoma may be observed over time (Choice A). Patients with macroprolactinomas or symptomatic tumors of any size (as with this patient) should be treated with dopaminergic agonists (eg, cabergoline, bromocriptine), which can normalize prolactin levels and reduce tumor size. Patients who fail to respond or who have very large tumors (>3 cm) should be referred for transsphenoidal resection.
Lichen
Lichen sclerosus: Autoimmune. Thin, dry, wrinkled skin. Risk for cancer
Lichen simplex: hyper plastic response to itching/scratching. Thick, leathery skin
Lichen planus: Autoimmune. Erosive, red, ulceration
Cortisol Insufficiency
Primary versus central adrenal insufficiency
Primary
Central** (secondary/pituitary; tertiary/hypothalamic)**
Most common cause
Autoimmune
Chronic glucocorticoid therapy
Cortisol
↓
↓
ACTH
↑
↓
Aldosterone
↓
Normal
Clinical features
Severe symptoms Hyperpigmentation Hyperkalemia Hyponatremia Hypotension
Less severe symptoms No hyperpigmentation No hyperkalemia Possible hyponatremia
The diagnosis of central AI begins with measurement of morning cortisol (low) and ACTH (low in central AI; high in primary AI). Aldosterone levels are low in primary AI but normal in central AI as aldosterone is regulated primarily by the renin-angiotensin-aldosterone system, not the pituitary (Choices A and B). In primary AI, aldosterone deficiency causes renal sodium wasting, leading to hyponatremia. Although hyponatremia may occur in central AI (possibly from impaired free water excretion due to cortisol deficiency), it is generally mild. Also, mild hypotension can occur due to decreased peripheral arterial resistance.
Stroke
This patient with deterioration of neurologic status 2 days after an ischemic strokemost likely had a hemorrhagic transformation (HT). HT is a common complication of ischemic stroke, especially when the stroke affects a large area (as in this patient), is due to an embolic cause, or has been treated with thrombolytics. Manifestations typically arise <48 hours after the initial event and are characterized by deterioration in the patient's neurologic status. Emergent noncontrast CT scan of the head is required to evaluate for HT as urgent surgical decompression is often needed.
Central Retinal Artery Occlusion
The most likely diagnosis is central retinal artery occlusion (CRAO) secondary to embolism. Painless loss of monocular vision is the usual presenting symptom. Risk factors include carotid artery disease, endocarditis, cardiac valvular disease, long bone fracture, hypercoagulable conditions, vasculitis, atrial myxoma, etc. It occurs when a severe, abrupt diminution of blood flow through the central retinal artery causes ischemia of the inner retina. (Remember that the ophthalmic artery is the first intracranial branch of the internal carotid artery. It supplies blood to the eye via the (1) central retinal artery, which is an end artery that supplies the inner retina, and the (2) ciliary branches, which supply the choroids and anterior portion of globe). Embolism of the retinal artery is the most common cause of ocular stroke. Emboli may travel to the distal branches of the retinal artery, causing loss of only a section of the visual field. It is commonly associated with amaurosis fugax before the occlusion (as in this patient). Visual acuity is typically 20/800 (6/240) or worse. Fundoscopy reveals diffuse ischemic retinal whitening and cherry red spots (typical but not specific for CRAO).
CRAO is an ophthalmologic emergency. A delay in treatment may result in permanent loss of vision. Immediate intervention includes ocular massage, which dislodges the embolus to a point further down the arterial circulation and improves retinal perfusion. Medical management and anterior chamber paracentesis to lower the intraocular pressure may be used, but ocular massage has the most rapid action. Carbogen therapy (5 % CO2 and 95% O2) or hyperbaric oxygen (HBO) therapy have been shown to be beneficial if given early.
Entamoeba Histolytica

This patient who recently emigrated from Mexico has abdominal pain, fever, leukocytosis, and a liver abscess on imaging. Given his young age, the absence of animal contact, and history of dysentery a few months ago, the most likely etiology is an amebic abscess caused by the intestinal protozoan, Entamoeba histolytica. The differential diagnosis includes pyogenic (bacterial) abscess and hydatid cyst caused by Echinococcus. However, bacterial abscesses generally occur in older patients with underlying medical conditions (eg, diabetes or hepatobiliary disease) or following peritonitis. Echinococcus cysts are not associated with fever, are frequently asymptomatic, and require contact with animals (eg, dogs, sheep); eosinophilia can occur if there is antigenic material leakage.
E histolytica infection (amebiasis) is most common in areas of poor sanitation. Most infected patients are asymptomatic but those with symptoms often develop dysentery. Extraintestinal infection is rare and generally limited to the liver, where the organisms form an abscess. The presentation is similar to a bacterial pyogenic abscess, including fever and right upper quadrant pain. Elevated alkaline phosphatase is common and elevated transaminases may be seen. Imaging typically shows a solitary lesion, generally found in the right lobe of the liver. Serologic testing for E histolytica antibodies confirms the diagnosis. Stool microscopy is insensitive by the time a liver abscess has formed (generally months after the initial infection).
Treatment of amebic liver abscess is with metronidazole (>90% cure with oral therapy). A luminal agent (ie, paromomycin) is also required to eradicate intestinal colonization. Drainage is not recommended routinely due to the high response rate to appropriate antiamebic therapy and the risk of rupture into the peritoneum. Drainage is reserved for mass effect, imminent rupture, or when the diagnosis remains uncertain or the patient is not improving with therapy. In contrast, large hydatid cysts due to Echinococcus can be treated with aspiration in combination with albendazole (Choice C).
Cavernous Sinus Thrombus
23 year old bitten with insect on cheek presenting with headache, fever, swollen cheeks, swollen eyes, restricted ocular movement
The most likely diagnosis in this patient is infectious cavernous sinus thrombosis (CST). Because the facial/ophthalmic venous system is valveless, uncontrolled infection of the skin, sinuses, and orbit can spread to the cavernous sinus. Inflammation of the cavernous sinus subsequently results in life-threatening CST and intracranial hypertension. Headache is the most common symptom and can become intolerable. A low-grade fever and periorbital edema usually occur several days later secondary to impaired venous flow in the orbital veins. Vomiting is also a result of intracranial hypertension, and fundoscopy may reveal papilledema.


Cranial nerves III, IV, V, and VI pass through the cavernous sinus, which has anastomoses crossing midline. As a result, unilateral symptoms (eg, headache, binocular palsies, periorbital edema, hypoesthesia, or hyperesthesia in V1/V2 distribution) can rapidly become bilateral. Magnetic resonance imaging with magnetic resonance venography is the imaging modality of choice for diagnosis of CST. Treatment includes broad-spectrum intravenous antibiotics and prevention or reversal of cerebral herniation.
Orbital Cellulitis
Preseptal vs orbital cellulitis
Diagnosis
Preseptal cellulitis
Orbital cellulitis
Clinical features
Eyelid erythema & swelling Chemosis
Symptoms of preseptal cellulitis PLUS Pain with EOM, proptosis &/or ophthalmoplegia with diplopia
Treatment
Oral antibiotics
Intravenous antibiotics ± Surgery
EOM = extraocular movements.
Preseptal cellulitis is a mild infection of the eyelid anterior to the orbital septum and most commonly results from local trauma (eg, insect bite, wound).
Orbital cellulitis is a serious bacterial infection located posterior to the orbital septum and involves the muscles of extraocular movement. This infection usually results from contiguous extension from another source of infection (eg, sinusitis, dental abscess, preseptal cellulitis). Patients often have leukocytosis and eyelid edema and erythema. A clinical diagnosis is based on signs of extraocular muscle involvement, such as painful extraocular movements or ophthalmoplegia (ie, eye muscle weakness or paralysis), as shown in this patient with limited left eye adduction. Additional signs include visual changes (eg, poor acuity, diplopia) and proptosis.
Treatment is intravenous antibiotics and, if an abscess is present, surgical drainage. Severe complications include permanent visual impairment (eg, optic nerve involvement) and intracranial extension (eg, infection, cavernous sinus thrombosis)
Preseptal:
Preseptal cellulitis must be differentiated from orbital cellulitis, a more severe infection of the space posterior to the orbital septum that usually results from contiguous spread from another source of infection (eg, sinusitis, dental abscess, preseptal cellulitis). Unlike orbital cellulitis, preseptal cellulitis does not involve intraorbital structures such as orbital fat or the extraocular muscles. Therefore, preseptal cellulitis can be differentiated from orbital cellulitis by the absence of signs indicative of:
Extraocular muscle involvement: ophthalmoplegia (ie, eye muscle weakness or paralysis), painful eye movements, visual changes
Orbital fat involvement: proptosis

Toxo

This patient with HIV has neurologic symptoms (headache, confusion, focal deficits), fever, and evidence of ring-enhancing lesions on MRI, strongly suggesting toxoplasmosis.
Endocarditis
Microbiology & clinical associations of infective endocarditis
Staphylococcus aureus
Prosthetic valves Intravascular catheters Implanted devices (eg, pacemaker/defibrillator) Intravenous drug users
Viridans group streptococci
Gingival manipulation Respiratory tract incision or biopsy
Staphylococcus epidermidis
Prosthetic valves Intravascular catheters Implanted devices
Enterococci
Nosocomial urinary tract infections
Streptococcus gallolyticus (S bovis)
Colon carcinoma Inflammatory bowel disease
Fungi (eg, Candida species)
Immunocompromised host Intravascular catheters Prolonged antibiotic therapy
A variety of microorganisms can cause IE, and certain bacteria are more frequently associated with specific clinical conditions. Staphylococcal infection is the most common cause of healthcare-associated IE; streptococcal infection is a common cause of community-acquired IE. The enterococci species (eg, Enterococcus faecalis) are another common (30%) cause of nosocomial-acquired endocarditis, particularly in those with associated nosocomial urinary tract infections. Given this patient's history of pyelonephritis and persistent dysuria, he likely has urinary tract colonization of enterococci species. The bacteremia in this patient likely occurred through urinary tract manipulation from the recent cystoscopy, leading to IE.
Acne
Initial management for inflammatory acne includes topical retinoids and benzoyl peroxide. However, most patients with moderate or moderate-to-severe inflammatory acne require topical antibiotics (eg, erythromycin, clindamycin). Oral antibiotics (eg, tetracyclines) are reserved for patients with severe or nodular acne and for moderate acne unresponsive to topical antibiotics. Oral antibiotics are also considered in patients with widespread acne (eg, on the back or upper arms) that makes topical therapy impractical.
Hypertension, Hypokalemia


Lung Breathing
Measurement of airway pressures can be useful in mechanically ventilated patients. The peak airway pressure (the maximum pressure measured as the tidal volume is being delivered) equals the sum of the resistive pressure (flow x resistance) and the plateau pressure.
Peak airway pressure = resistive pressure + plateau pressure
The plateau pressure is the pressure measured during an inspiratory hold maneuver, when pulmonary airflow and thus resistive pressure are both 0. It represents the sum of the elastic pressure and positive end-expiratory pressure (PEEP).
Plateau pressure = elastic pressure + PEEP
Elastic pressure is the product of the lung's elastance and the volume of gas delivered. Because elastic recoil is inversely related to lung compliance, the elastic pressure can be calculated as tidal volume/compliance. Decreased compliance (eg, pulmonary fibrosis) causes stiffer lungs and higher elastic pressure.
Increased peak pressure associated with an unchanged plateau pressure suggests a pathological process causing increased airway resistance, such as bronchospasm, mucus plug, or endotracheal tube obstruction. Elevation of both peak and plateau pressures indicates a process causing decreased pulmonary compliance, such as pulmonary edema, atelectasis, pneumonia, or right mainstem intubation.

Clozapine
This patient has signs and symptoms consistent with an acute exacerbation of schizophrenia and requires treatment with antipsychotic medication. Review of his medication history indicates that he is treatment resistant (poor response to at least 2 antipsychotic trials). The patient has failed 3 trials, including the first-generation antipsychotic haloperidol and 2 second-generation antipsychotics (risperidone, olanzapine). With the exception of clozapine, there is no evidence that one antipsychotic is more effective than another. Clozapine is unique in that it has shown superiority in treatment-resistant schizophrenia and schizophrenia associated with persistent suicidality.
Pediatric Constipation
Risk factors
Initiation of solid food & cow’s milk Toilet training School entry
Clinical features
Painful/hard bowel movements Stool withholding Encopresis
Complications
Anal fissures Hemorrhoids Enuresis/urinary tract infections
Treatment
↑ Dietary fiber & water intake Limit cow’s milk intake to less than 24 oz Laxatives± Suppositories, enema
Toddlers are at risk for constipation due to multiple transitional events, including dietary changes, toilet training, and day care or school initiation. Straining, hard stools, and anal fissures in this patient are characteristic of constipation and likely exacerbated by poor dietary habits (eg, little fiber, minimal water).
Prevention and treatment of constipation are necessary as the cycle of straining and painful defecation can lead to avoidance of defecation, or stool withholding. If the rectum progressively dilates, the internal anal sphincter relaxes in response to the increasing pressure, resulting in encopresis (fecal incontinence). The stool burden also decreases bladder capacity and can contribute to enuresis.
Behavioral modifications include increasing water and fiber intake, limiting cow's milk to <24 oz a day, and sitting on the toilet after each meal. If dietary modifications are unsuccessful, as in this case, oral laxatives (eg, polyethylene glycol, mineral oil) should be initiated and titrated to produce daily soft bowel movements. Considered safe and effective, laxatives soften stool, which helps to break the cycle of painful defecation and stool withholding.
Alzheimers
In patients with early AD, MRI may be normal. However, temporal and parietal lobe atrophy, most prominent in the medial temporal lobes and hippocampi, is typically seen in later stages of AD.
Gestational DM
Fasting ≤95 mg/dL (5.3 mmol/L)
1-hour postprandial ≤140 mg/dL (7.8 mmol/L)
2-hour postprandial ≤120 mg/dL (6.7 mmol/L)
Pressure Ulcer
This patient has an extended nursing facility stay with decreased mobility and evidence of significant neurologic injury, and now has a stage II pressure ulcer at the heel and a stage I lesion at the sacrum. Besides reduced mobility, risk factors for pressure ulcers include malnutrition, abnormal mental status (eg, dementia), decreased skin perfusion, and reduced sensation.
Standard interventions to prevent pressure ulcers in high-risk patients include:
Proper patient positioning
Mobilization
Careful skin care
Moisture control
Maintenance of nutrition
Patients at risk for pressure ulcers should be cared for on beds with features that provide pressure redistribution and reduce focal pressure. Effective modifications include air-fluidized beds, pressure-relieving overlays (eg, sheepskin), higher-specification foam mattresses, and active repositioning systems or alternating pressure supports. In addition, patients should be repositioned by the nursing staff at regular intervals (eg, every 2 hours), although there is less evidence to support this intervention.

Refeeding Syndrome

Chronic starvation and acute refeeding are potentially life-threatening in patients with anorexia nervosa. Refeeding syndrome is the constellation of pathologic derangements resulting from a surge in insulin activity as the body resumes anabolism (Flow chart). Carbohydrate ingestion, whether enteral or intravenous, causes pancreatic insulin secretion and cellular uptake of phosphorus, potassium, and magnesium. Phosphorus is the primary deficient electrolyte as it is required for energy (adenosine triphosphate). Deficiencies in potassium and magnesium potentiate cardiac arrhythmias in a heart that is already atrophic from prolonged malnutrition. Therefore, aggressive initiation of nutrition without adequate electrolyte repletion can quickly precipitate cardiopulmonary failure. This patient has signs of volume overload from heart failure based on increased pulse and respiratory rate, jugular venous distention, and bibasilar lung crackles.
Renal, bladder US

This child's clinical presentation and laboratory studies are consistent with her first urinary tract infection (UTI). The fever, dysuria, and suprapubic/flank pain are suggestive of renal involvement. Pyuria (>5 white blood cells/hpf) and bacteriuria (50,000 colony-forming units/mL from a catheterized specimen) confirm the infection. Children age <2 years are at increased risk of complications from UTI and should be treated with 1-2 weeks of antibiotics. In addition, all children age <2 years with a first febrile UTI should undergo a renal and bladder ultrasound to evaluate for any anatomic abnormalities that might predispose the child to UTIs. Ideally, the ultrasound is performed after improvement of fever and symptoms to minimize false positive results from acute inflammation. If the patient has persistent or worsening symptoms, an ultrasound should be performed immediately to assess for renal abscess.
Retropharyngeal Abscess

The retropharyngeal space is a deep compartment of the neck defined anteriorly by the buccopharyngeal fascia and constrictor muscles of the pharynx and posteriorly by the alar fascia. It communicates laterally with the parapharyngeal space. This patient has a retropharyngeal abscess with neck pain, odynophagia, and fever following penetrating trauma to the posterior pharynx. Examination findings can include nuchal rigidity and bulging of the pharyngeal wall. Although deep space infections of the neck have become less common since the advent of widespread antibiotic use, they can progress rapidly with potentially fatal complications.
Infection within the retropharyngeal space drains inferiorly to the superior mediastinum. Spread to the carotid sheath can cause thrombosis of the internal jugular vein and deficits in cranial nerves IX, X, XI, and XII. Extension through the alar fascia into the "danger space" (between the alar and prevertebral fasciae) can rapidly transmit infection into the posterior mediastinum to the level of the diaphragm. Acute necrotizing mediastinitis is a life-threatening complication characterized by fever, chest pain, dyspnea, and odynophagia, and requires urgent surgical intervention.
Ludwig angina is a rapidly progressive bilateral cellulitis of the submandibular and sublingual spaces, most often arising from an infected mandibular molar. Clinical findings include fever, dysphagia, odynophagia, and drooling.
Hereditary Thrombophilias

The most commonly found disorder is factor V Leiden (FVL), especially in Caucasian patients (4%-5% prevalence). Most patients with FVL have an autosomal dominant point mutation in the gene for factor V that makes it unable to respond to activated protein C, an innate anticoagulant. This mutation leads to slowed degradation of procoagulant active factor V, leading to continued thrombin formation and to slowed degradation of active factor VIII. Prothrombin time and activated partial thromboplastin time can be normal as the major procoagulant effects are due to continued thrombin formation; the elements of the coagulation cascade that can be assessed by these laboratory tests are less likely to be predominantly affected.
Patients who inherit FVL are at an increased risk for DVT and PE, although not all express this phenotype as most are heterozygous. Those who are homozygous are at an even greater risk.
IDA in children
prematurity
Lead exposure
<1 yrs:
Delayed introduction of solids
(ie, exclusive breastfeeding after 6 months)
Cow's, soy, or goat's milk
Older than 1 yrs:
>24 oz/day cow's milk
<3 servings/day iron-rich foods
Iron deficiency is the most common nutritional deficiency in children. An infant's iron stores are affected by the maternal iron stores, prenatal or perinatal hemorrhage, and the gestational age of the infant at delivery; also, prematurity is a risk factor for iron deficiency. Term infants usually have adequate iron stores for the first 6 months of life. After 6 months, inadequate dietary intake becomes the most important cause of iron deficiency. Early introduction or excessive intake of cow's milk is problematic as cow's milk has low iron content and bioavailability and can cause occult intestinal blood loss in infants. Children should not be started on cow's milk until age 1 year, and children age ≥1 year should consume <24 ounces/day (ie, consumption of >24 ounces [700 mL]/day is a risk factor for iron deficiency). A typical glass is about 8 ounces.
Children with iron deficiency are often asymptomatic and may not have telltale symptoms such as pica, fatigue, or pallor. Therefore, universal screening is recommended by age 1 year, and the diagnosis is typically based on a complete blood count, typically showing a low hemoglobin, low mean corpuscular volume, and elevated red blood cell distribution width. The reticulocyte count is classically low (because the bone marrow with iron deficiency cannot increase reticulocyte production), although a low (<2%) reticulocyte index (reticulocyte count × hematocrit / normal hematocrit) is a better indicator of hypoproliferative anemia. A peripheral smear would be expected to show microcytic hypochromic erythrocytes, although it is usually not needed in the initial workup. Further testing (eg, iron studies) is not necessary in children with the classic presentation. The most cost-effective approach to treatment is empiric oral iron therapy. Hemoglobin should be rechecked in 4 weeks; if the hemoglobin level has risen 1 g/dL, the oral iron therapy should be continued for 2-3 months after the hemoglobin normalizes to replete iron stores.
Liver Cirrhosis
If the initial evaluation (history, examination, basic laboratory studies) reveals clinical findings consistent with alcohol liver disease, further evaluation for an underlying cause is not indicated. Instead, management goals should include identifying and treating reversible factors and potential complications (eg, variceal hemorrhage, hepatocellular carcinoma). Esophageal varices are the major cause of morbidity and mortality and can occur in 30%-60% of patients with cirrhosis. As a result, all patients with cirrhosis should undergo screening endoscopy to exclude varices, determine risk of variceal hemorrhage, and indicate strategies for prevention of hemorrhage.
Abdominal CT: not required of US and LFT
Biopsy: not necessary if clinical diagnosis
Ammonia: only check for symptomatic encephalopathy

A transjugular intrahepatic portosystemic shunt is often used as salvage therapy in patients with refractory ascites or esophageal varices who have failed endoscopic or medical management.

Multiple System Atrophy
The clinical presentation of this patient is suggestive of multiple system atrophy (Shy-Drager syndrome), which is a degenerative disease characterized by the following:
Parkinsonism
Autonomic dysfunction (postural hypotension, abnormal sweating, disturbance of bowel or bladder control, abnormal salivation or lacrimation, impotence, gastroparesis, etc.)
Widespread neurological signs (cerebellar, pyramidal or lower motor neuron)
Always consider Shy-Drager syndrome when a patient with Parkinsonism experiences orthostatic hypotension, impotence, incontinence, or other autonomic symptoms. The accompanying bulbar dysfunction and laryngeal stridor may be fatal. Anti-Parkinsonism drugs are generally ineffective, and treatment is aimed at intravascular volume expansion with fludrocortisone, salt supplementation, alpha-adrenergic agonists, and application of constrictive garments to the lower body.
Secondary Pneumonia
Secondary bacterial pneumonia is the most common complication of influenza but is rare in young individuals (most are age >65). An exception occurs with community-associated methicillin-resistant Staphylococcus aureus (CA-MRSA), an organism that preferentially attacks young patients with influenza. CA-MRSA causes severe, necrotizing pneumonia that is rapidly progressive and often fatal. Manifestations include high fever, productive cough with hemoptysis, leukopenia, and multilobar cavitary infiltrates. Most patients require admission to the intensive care unit and broad-spectrum, empiric antibiotics, including either vancomycin or linezolid.
Carpal Tunnel
Nerve conduction not EMG
Vertigo
Disease
Acute/Chronic
Constant/Episodic
Others
BPPV
Chronic
Episodes
No tinnitus/hearing loss. Head change
Meniere
Chronic
Episodes
Tinnitus, fullness, hearing loss
Labyrinthritis
Acute
Improving
Hearing loss, tinnitus, imbalance
Schwannoma
Chronic
Worsening
Hearing loss, tinnitus, imbalance
Otosclerosis
Chronic
Worsening
Conductive hearing loss, no vertigo
Dopamine pathways

Antipsychotic medication effects (dopamine antagonism) in dopamine pathways
Pathway
Effect
Mesolimbic
Antipsychotic efficacy
Nigrostriatal
Extrapyramidal symptoms: Acute dystonia, akathisia, parkinsonism
Tuberoinfundibular
Hyperprolactinemia
The mesolimbic pathway extends from the ventral tegmental area to the limbic system. Decreased dopamine activity in this pathway accounts for the therapeutic effects of antipsychotics. Increased dopamine activity in the mesolimbic pathway accounts for the euphoria that accompanies drug use, as well as the delusions and hallucinations experienced in schizophrenia.
The nigrostriatal pathway extends from the substantia nigra to the basal ganglia and is involved in the coordination of movement. Decreased dopamine activity in the nigrostriatal pathway causes the extrapyramidal side effects associated with antipsychotic use, as well as signs and symptoms of Parkinson disease. Increased dopamine activity in the nigrostriatal pathway is thought to be involved in some movement disorders such as chorea and tics.
Microcytic Anemia

Acquired sideroblastic anemia frequently manifests as microcytic hypochromic anemia simulating iron-deficiency anemia. Usually two groups of RBC can be demonstrated on microscopy - hypochromic and normochromic ("dimorphic" RBC population). Besides that, iron studies typically reveal increased serum iron concentration and decreased total iron binding capacity (TIBC), which helps to differentiate sideroblastic anemia from iron-deficiency anemia.
DVT Vs PE
PE: prophylactic anticoagulation
DVT: confirm diagnosis
Anorexia
Anorexia nervosa
Clinical features
Underweight (BMI <18.5 kg/m2) Fear of weight gain, distorted body image
Treatment
Psychotherapy (individual, family, group) Nutritional rehabilitation Olanzapine if severe/refractory
Indications for hospitalization
Bradycardia (<40/min), dysrhythmia Hypotension (<80/60 mm Hg), orthostasis Hypothermia (less than 35 C) Electrolyte disturbance, marked dehydration Organ compromise (renal, hepatic, cardiac) <70% expected weight (BMI <15 kg/m2)
Pharmacotherapy is not a first-line treatment for AN. First-line treatment consists of weight restoration through nutritional rehabilitation and psychotherapy. Studies show that cognitive-behavioral therapy (CBT) is the most effective; however, other types of psychotherapy (eg, psychodynamic, family) may also be beneficial. CBT for AN targets disordered eating behaviors and cognitive distortions about weight. It also relieves associated (comorbid) depressive symptoms that are commonly seen in AN.
Psychotherapy
Biofeedback: identify/control responses to stimuli (pain triggered by emotional stressors)
DBT: borderline personality
Rotavirus

Live virus vaccinations should not be administered to pregnant women due to theoretical risk of fetal infection. However, live virus vaccinations can be safely administered to household contacts of pregnant women because the virus is weak and not contagious. Vaccination of household contacts reduces the potential spread of infection to patients who cannot receive vaccinations.
AOM
Serous otitis media, or otitis media with effusion, can be distinguished from AOM by the lack of acute inflammatory signs (eg, fever, tympanic membrane bulging). This effusion may be asymptomatic and present in the weeks following AOM treatment or, if chronic, can lead to hearing loss.
Maltese Cross
AIDS brain lesions
Toxoplasmosis: MRI reveals multiple, ring-enhancing, spherical lesions in the basal ganglia.
Progressive multifocal leukoencephalopathy lesions are non-enhancing, and do not produce mass effects.
The presence of EBV DNA in the CSF is specific for this condition. MRI reveals a weakly ring-enhancing mass that is usually solitary and periventricular.
CURB 65

Fibromuscular Dysplasia
In adults, approximately 90% of FMD cases occur in women. Recurrent headache caused by carotid artery stenosis or aneurysm is the most common presenting symptom. Pulsatile tinnitus, neck pain, or flank pain are also common, and symptoms of transient ischemic attack (eg, focal weakness, vision loss) may occur. Hypertension results from renal artery stenosis (RAS) leading to secondary hyperaldosteronism. An abdominal bruit may be present. In young patients, a subauricular systolic bruit is highly suggestive of FMD as carotid atherosclerosis should not be present. Even in older patients, such a bruit suggests FMD as the subauricular location indicates involvement of the internal carotid artery, which, in contrast with the carotid bulb, is not commonly affected by atherosclerosis.
Osteoid Osteoma
Osteoid osteoma is a benign, bone-forming tumor that typically occurs in adolescent boys. The femur (particularly the proximal bone), tibia, and spine are the most common sites affected. Patients develop increasing pain that is worse at night and is unrelated to physical activity. Pain relieved by nonsteroidal anti-inflammatory drugs (NSAIDs) is a classic feature that is strongly suggestive of the diagnosis; the absence of this finding should raise suspicion for alternate diagnoses.
Tenderness, deformity, or swelling may be present on examination; however, adolescents may have no focal examination findings. X-ray shows a characteristic small, round lucency with sclerotic margins and sometimes central ossification. NSAIDs are prescribed for symptomatic relief, and serial imaging is performed to monitor the lesion. Surgical resection is typically reserved for patients with refractory symptoms, as most lesions resolve spontaneously over several years.

Amyloidosis

Amyloidosis can cause multisystemic disease due to fibril deposition in tissues. Cardiac amyloidosis, a form of restrictive cardiomyopathy, should be suspected in patients who have manifestations of congestive heart failure (eg, progressive dyspnea, lower extremity edema, jugular venous distension, ascites) with echocardiographic findings of concentric left ventricular (LV) hypertrophy and nondilated LV cavity, especially in the absence of a history of hypertension. Right heart failure symptoms tend to predominate. As LV wall thickness increases (due to fibril deposition), LV cavity size decreases and a restrictive physiology develops. Atrial enlargement is common and cardiac conduction abnormalities may occur. Restrictive cardiomyopathy is less common than dilated or hypertrophic cardiomyopathy but is an important cause of heart failure with preserved ejection fraction. It may be idiopathic or due to infiltrative diseases (eg, sarcoidosis, amyloidosis), storage diseases (eg, hemochromatosis), or endomyocardial fibrosis.
Other clinical manifestations suggestive of amyloidosis include asymptomatic proteinuria (seen in this patient) or nephrotic syndrome, waxy skin, anemia (seen in this patient), easy bruising with ecchymosis, hepatomegaly, gastrointestinal bleeding, early satiety (also seen in this patient), subcutaneous nodules, enlarged tongue, and peripheral or autonomic neuropathy.
D Xylose

Normal: malabsorption in chronic pancreatitis
Abnormal: celiac disease, whipple
False abnormal: delayed gastric emptying, impaired GFR, bacterial overgrowth
A false-positive D-xylose test can be seen in SIBO due to bacterial fermentation of the ingested D-xylose dose before it can be absorbed. However, SIBO is unlikely in this case as treatment with rifaximin did not significantly change D-xylose absorption.
Pellagra
Deficiency of niacin (vitamin B3) leads to pellagra, which is characterized by diarrhea, dermatitis, dementia, and if severe, death. Pellagra is common in resource-limited countries where the main diet consists of cereal or corn, but can also be seen in people with bowel disease that interferes with vitamin absorption.
Pellagra typically presents with gastrointestinal complaints (eg, nausea, abdominal pain, epigastric discomfort) along with glossitis (eg, swollen, red tongue) and watery diarrhea. The characteristic dermatitis seen in pellagra occurs in sun-exposed areas and resembles a sunburn; it is also typically bilateral and symmetric. As the rash progresses, the skin becomes hyperpigmented and thickened. Mental status changes can range from poor concentration to irritability, aggressiveness, and dementia. Death can occur in severe niacin deficiency if untreated. Treatment of pellagra is niacin replacement.
Diarrhea
This patient with chronic nonbloody diarrhea and weight loss after multiple abdominal surgeries most likely has secretory diarrhea. Diarrhea can be divided into 3 main categories: watery, fatty, and inflammatory. Watery diarrhea can be further broken down into osmotic, secretory, and functional. Hallmarks of secretory diarrhea include larger daily stool volumes (>1 L/day) and diarrhea that occurs even during fasting or sleep. Secretory diarrhea most commonly occurs when luminal ion channels are disrupted in the gastrointestinal tract, resulting in a state of active secretion.
A helpful tool in distinguishing osmotic from secretory diarrhea is the stool osmotic gap (SOG), which calculates the difference between plasma osmolality (considered equivalent to measured stool osmolarity) and double the sum of sodium and potassium ions in stool (corresponding to calculated stool osmolality):
SOG = plasma osmolality - 2 × (stool sodium + stool potassium)
In osmotic diarrhea, nonabsorbed and unmeasured osmotically active agents are present in the gastrointestinal tract. These ions result in an elevated osmotic gap (SOG >125 mOsm/kg). By contrast, secretory diarrhea is due to increased secretions of ions; therefore, the difference between plasma osmolality and measured fecal sodium and potassium is significantly reduced (SOG <50 mOsm/kg).
Common causes of secretory diarrhea include bacterial infections (eg, Vibrio cholera), viral infections (eg, rotavirus), congenital disorders of ion transport (eg, cystic fibrosis), early ileocolitis, and postsurgical changes. Secretory diarrhea can occur after bowel resection or cholecystectomy when unabsorbed bile acids reach the colon and result in the direct stimulation of luminal ion channels. In addition, resection of the ileocecal area reduces the ability of the intestines to actively absorb sodium ions against the electrochemical gradient.
Inflammatory diarrhea is usually accompanied by either grossly bloody stools or positive occult blood testing. Patients also commonly report systemic symptoms such as fatigue and fever.
(Choice C) Intestinal dysmotility disorders, such as chronic intestinal pseudo-obstruction and irritable bowel syndrome, frequently have associated fatigue, nausea, and vomiting. Neither is associated with diarrhea during fasting.
(Choice D) Osmotic diarrhea is caused by the ingestion of osmotically active, poorly absorbable substances and is characterized by an elevated SOG. Lactose intolerance is a classic example.
Prader Willi

This patient has the characteristic features of Prader-Willi syndrome (PWS), a sporadic disorder due to maternal uniparental disomy. Normally, people inherit 2 active copies of each gene - 1 from the mother and 1 from the father. Patients with PWS inherit both copies of a section of chromosome 15 from their mother. The deletion of the paternal copy of chromosome 15q11-q13 results in poor suck and feeding problems in infancy followed by a life of compulsive binge-eatingand obesity-related problems. Other common manifestations are shown in the table.
Genetic testing is required to confirm diagnosis and begins with karyotype and methylation studies, followed by fluorescence in-situ hybridization, and then microsatellite probes. Management revolves around obesity and its complications. Patients benefit from a structured eating environment and strict limitation of food intake (eg, locks on refrigerator, close supervision). They should be screened for sleep apnea (central and obstructive) as well as type 2 diabetes mellitus. Some patients undergo growth hormone therapy to improve linear growth and body composition, including fat-free mass and bone density.
Primary Amenorrhea

This patient has primary amenorrhea, the absence of menarche in girls age ≥13 with no secondary sexual characteristics (or girls age ≥15 with secondary sexual characteristics [eg, axillary/pubic hair]). Initial evaluation is with a pelvic ultrasoundto determine the presence or absence of a uterus. In those with a uterus (such as this patient), the best next step is an FSH level, which helps distinguish between central and peripheral causes of amenorrhea in the hypothalamic-pituitary-ovarian (HPO) axis.
Central causes of amenorrhea (ie, hypothalamic, pituitary) have a low to normal FSH level due to either decreased GnRH (hypothalamic) or decreased FSH production/secretion (anterior pituitary).
Peripheral causes of amenorrhea (ie, ovarian) have a high FSH level. High FSH levels occur due to a lack of ovarian estrogen and inhibin production; a lack of feedback inhibition to the hypothalamus and pituitary results in constant FSH production. Anatomic defects (eg, imperforate hymen) are also a peripheral cause of amenorrhea but do not affect the HPO axis and, therefore, are associated with normal FSH levels.
Based on the FSH level, additional testing for specific etiologies is performed (eg, karyotype analysis, MRI of pituitary).
LCP
Legg-Calvé-Perthes disease
Pathogenesis
Idiopathic avascular necrosis of the femur
Clinicalfeatures
Boys age 3-12 Insidious hip pain, limp Restricted hip abduction, internal rotation Positive Trendelenburg sign
Diagnosis
X-ray Early stages: May be normal Later stages: Femoral head flattening, fragmentation, sclerosis MRI: Avascular/necrotic femoral head
Treatment
Non–weight bearing Splinting, possible surgical repair
This patient most likely has Legg-Calvé-Perthes disease (LCP), or idiopathic osteonecrosis (avascular necrosis) of the femoral head. LCP classically affects boys age 3-12, with peak incidence at age 6.
Patients typically have an antalgic gait (avoids weight bearing on the affected side due to pain) and dull, chronic lower extremity pain of insidious onset. The pain may affect the hip directly or present as referred thigh or knee pain, as in this patient. Diagnosis requires a high index of suspicion as initial x-rays may be normal. Persistent symptoms should prompt repeat imaging, which in later stages typically shows sclerosis of the femoral head with flattening and fragmentation. As the disease progresses, examination may reveal limited internal rotation and abduction of the hip. Proximal thigh atrophy and Trendelenburg sign may also be present.
Treatment is aimed at maintaining the femoral head within the acetabulum by avoiding weight-bearing activities and by splinting or surgery.

Slipped capital femoral epiphysis also presents with limp and insidious hip pain. Patients are typically adolescent and obese, neither of which is true in this patient. In addition, x-ray shows posterior displacement of the femoral head, unlike the normal x-rays in this patient.
Systemic Sclerosis
Systemic sclerosis
Pathogenesis
Progressive tissue fibrosis Vascular dysfunction
Clinical features
Systemic: Fatigue, weakness Skin: Telangiectasia, sclerodactyly, digital ulcers, calcinosis cutis Extremities: Arthralgias, contractures, myalgias Gastrointestinal: Esophageal dysmotility, dysphagia, dyspepsia Vascular: Raynaud phenomenon
Serology
Antinuclear antibody Anti-topoisomerase I (anti-Scl-70) antibody Anticentromere antibody
Complications
Lung: Interstitial lung disease, pulmonary arterial HTN Kidney: HTN, scleroderma renal crisis (oliguria, thrombocytopenia, MAHA) Heart: Myocardial fibrosis, pericarditis, pericardial effusion
HTN = hypertension; MAHA = microangiopathic hemolytic anemia.
Systemic sclerosis (SSc, often termed scleroderma) is characterized by connective tissue thickening due to fibroblast dysfunction and increased collagen and ground substance production. Cutaneous features include thickening of the skin that begins in acral sites (hands and feet) with edema that transitions to dermal sclerosis (sclerodactyly) and obliteration of skin appendages (eg, hair follicles, sweat glands). Vascular dysfunction (eg, Raynaud phenomenon) is present in most patients. Extradermal manifestations are common, especially in patients with more extensive skin involvement. Frequent complications include esophageal dysmotility, interstitial lung disease (eg, fatigue, breathlessness, fine crackles), and hypertension (due to renal involvement).
MG
Myasthenia gravis is a NMJ disorder caused by autoantibodies against acetylcholine receptors in the motor end plate. Patients typically have fluctuating and fatigable extraocular (eg, diplopia, ptosis) and bulbar (eg, dysarthria, dysphagia) muscle weakness. They may also experience symmetric proximal weakness involving the neck (eg, difficulty holding up the head) and upper extremities (eg, difficulty combing hair). Sensation, reflexes, muscle bulk/tone, and autonomic function are usually intact.
Sinus Bradycardia
Sinus bradycardia can occur normally in adolescents and younger adults, in well-conditioned athletes, and in some elderly patients, especially during sleep. Pathologic causes include sick sinus syndrome, myocardial ischemia or infarction, obstructive sleep apnea, hypothyroidism, increased intracranial pressure, and medications.
The first step in symptomatic patients is to identify and treat reversible causes, followed by administration of intravenous (IV) atropine for initial treatment of the bradycardia and hypotension. In patients with an inadequate response, further treatment options include IV epinephrine or dopamine, or transcutaneous pacing.
Pediatric Tumors


Low-grade astrocytoma, particularly pilocytic astrocytoma, is the most common brain tumor in children. Presenting symptoms vary depending on tumor location. A supratentorial tumor classically presents with seizures, weakness, and sensory changes, whereas a posterior fossa tumor typically presents with cerebellar dysfunction (eg, ataxia, dysmetria). Signs of increased intracranial pressure (ICP) (eg, early-morning headache/vomiting, papilledema) can occur as the tumor enlarges, regardless of tumor location.
Ependymomas are glial cell tumors that arise from the ependymal cell lining of the ventricles and spinal cord. In children, the most common site is the fourth ventricle in the posterior fossa, where tumor expansion leads to obstruction of cerebrospinal fluid and increased ICP. Weakness and seizures are less common with ependymomas.
Medulloblastoma is the second most common tumor of the posterior fossa in children. These infratentorial tumors typically arise from the cerebellar vermis and present with vomiting, headaches, and ataxia.
Glioblastomas are supratentorial, high-grade astrocytic tumors that typically arise in the cerebral hemispheres and present with seizures and signs of increased ICP. However, they are much less common than low-grade astrocytomas in children.
Warfarin

Warfarin is a coumarin anticoagulant most commonly used in the setting of thrombophilia and cardiac conditions that predispose to intracardiac thrombus formation. Warfarin functions by inhibiting synthesis of the vitamin K-dependent clotting factors II, VII, IX, and X, as well as the vitamin K-dependent anticoagulant proteins C and S. As a result, it can cause a decrease in measured levels of protein S. This may lead to an incorrect diagnosis of inherited protein S deficiency. If possible, vitamin K antagonists such as warfarin should be discontinued for 2 weeks prior to evaluating protein S levels.
Meningitis in Children
Causes of meningitis in children
<3 months
Group B Streptococcus Escherichia coli & other gram-negative bacteria Listeria monocytogenes Herpes simplex virus
3 months to 10 years
Streptococcus pneumoniae Neisseria meningitidis
>11 years
Neisseria meningitidis
This patient has signs of meningitis (fever, lethargy, Brudzinski sign) and petechial rash. Of the available answer choices, Neisseria meningitidis is the most likely cause. N meningitidis is the second most common cause of bacterial meningitis in children age 3 months to 10 years (behind Streptococcus pneumoniae) and is the most common cause among adolescents. The risk of acquiring meningococcal disease is 10-fold higher in children age <2 years compared with older children.
Meningococcal disease often presents with a petechial rash on the extremities that may become purpuric as the infection progresses. The disease progresses rapidly and carries very high morbidity and mortality rates even with appropriate treatment. Empiric therapy for suspected bacterial meningitis should include a third-generation cephalosporin (eg, ceftriaxone) and vancomycin. N meningitidis is generally susceptible to penicillin and third-generation cephalosporins.
This infant's hypothermia, lethargy, and low white blood cell count with left shift are highly concerning for neonatal sepsis, a systemic bacterial infection in infants age <28 days. His full fontanelles and apnea are concerning for the presence of meningitis as well. Group B Streptococcus (GBS) is the most common cause of both early onset (age ≤7 days) and late-onset neonatal sepsis as well as meningitis in young infants.
The incidence of vertically transmitted (ie, mother to infant during delivery), early-onset GBS disease has decreased thanks to universal screening of pregnant women and administration of intrapartum antibiotic prophylaxis (IAP) to GBS-colonized mothers. IAP is not necessary for planned cesarean delivery without labor or rupture of membranes, as GBS transmission is low in such settings (because the infant does not go through the birth canal).
However, IAP does not eliminate colonization. Therefore, it has not changed the incidence of horizontally transmitted (eg, person to person on unwashed hands), late-onset GBS sepsis, as seen in this patient, who was likely exposed to GBS at home from his colonized mother.
Because of the comparatively high incidence of sepsis in neonates, the nonspecific presenting manifestations (eg, irritability, hypothermia or hyperthermia, high or low white blood cell count with bandemia), and the high morbidity and mortality, blood, urine, and cerebrospinal fluid cultures should be obtained in all neonates with suspected sepsis, and these patients should be treated with empiric parenteral antibiotic therapy.
Epidural Spinal Cord Compression
Although imaging (MRI) plays an important role in the diagnosis of ESCC, intravenous glucocorticoids should be given without delay in a patient with suspected ESCC. Glucocorticoids decrease vasogenic edema (caused by obstructed epidural venous plexus), help alleviate pain, and may restore neurologic function. Once imaging confirms ESCC, neurosurgical consultation is typically required.
Tinea
HIV infection increases the risk for tinea versicolor, which typically presents with hypopigmented macules.
Doctor gifts
To safeguard patients and preserve the reputation of doctors, the American Medical Association (AMA) guidelines (Opinion 8.061 - Gifts to Physicians from Industry) suggest accepting nonmonetary gifts from interested parties only if the gifts directly benefit patient care and are of small monetary value (eg, unbiased educational materials, drug samples). No gifts of cash or high value, or with implied reciprocity, should be accepted.
Nephrotic Syndrome

Vitamin Deficiencies

Zinc is absorbed mostly in the duodenum and jejunum, and deficiency can be due to malabsorption (eg, Crohn disease, celiac disease), bowel resection, gastric bypass, or poor nutritional intake. In addition, patients dependent on parenteral nutrition (PN) are at risk for trace mineral deficiency (eg, zinc, selenium, copper, chromium) due to inadequate supplementation of parenteral intake. Comorbid diarrhea and malabsorption further increase the risk of trace mineral deficiency in patients on PN due to excessive gastrointestinal losses.
HIV PEP
The exposed health care worker should have HIV testing immediately to establish baseline serologic status; testing should be repeated at 6 weeks, 3 months, and 6 months. In addition to obtaining baseline serological studies, PEP should be started urgently, preferably in the first few hours following exposure (Choice D). If possible, workers should be relieved of duties immediately to initiate PEP (eg, operating room personnel should scrub out of the procedure). Standard PEP consists of triple-drug therapy (Table) (Choice C). Tenofovir-emtricitabine with raltegravir is preferred due to a low side effect profile and few drug-to-drug interactions. PEP should be continued for 4 weeks.
>3-drug regimen recommended:
Two nucleotide/nucleoside reverse transcriptase inhibitors (eg, tenofovir, emtricitabine)
Plus
Integrase strand transfer inhibitor (eg, raltegravir), protease inhibitor, or non-nucleoside reverse transcriptase inhibitor
Laryngomalacia

Laryngomalacia, which causes chronic stridor in infants, is caused by "floppy" supraglottic structures that collapse during inspiration. Stridor from laryngomalacia usually begins in the neonatal period and is loudest at age 4-8 months. Presentation includes inspiratory stridor worse in the supine position and exacerbated by feeding or upper respiratory illnesses; prone positioning improves symptoms. The diagnosis is made clinically but can be confirmed with visualization of the larynx by direct or flexible fiber-optic laryngoscopy. Findings include an omega-shaped (Ω) epiglottis and collapse of the supraglottic structures during inspiration.
Most infants with laryngomalacia will feed, grow, and ventilate normally with spontaneous resolution of stridor by age 18 months. However, the majority of patients will have symptoms of gastroesophageal reflux (eg, vomiting, arching of the back with feeds, poor weight gain) and should be treated accordingly (eg, upright positioning after feeds, acid reducers).

Chronic inspiratory worse in supine: laryngomalacia, laryngoscopy
Biphasic and feeding difficulties: vascular ring (aortic arch around esophagus/trachea), barium swallow
Acute: foreign body
Systemic symptoms: anterior mediastinal mass/lymphoma, chest xray
Dysphagia, neck pain, fever: retropharyngeal abscess, neck radiography
Hemochromatosis
Joint Pain X ray
Osteoarthritis: narrowing of joint and osteophytes
Gout: punched out erosions
Pseudogout: chonedrocalcinosis
RA: periarticular osteopenia with joint margin erosions

Wiskott Aldrich
Wiskott-Aldrich syndrome
Etiology
X-linked recessive defect in WAS protein gene Impaired cytoskeleton changes in leukocytes, platelets
Clinical features
Eczema Microthrombocytopenia (small platelets, low platelet count) Recurrent infections
Treatment
Stem cell transplant
This patient's eczema (itchy, red, scaly skin), microthrombocytopenia (small and low number of platelets), and recurrent infections are consistent with Wiskott-Aldrich syndrome (WAS). WAS is caused by an X-linked recessive defect in the WAS gene. This gene is primarily expressed in hematopoietic cells and regulates cytoskeleton remodeling in response to cell signaling. In WAS, the actin cytoskeleton in white blood cells is abnormal, resulting in immune dysfunction due to impaired cellular migration and immune synapse formation. Patients are at increased risk for recurrent bacterial, viral, and fungal infections.
Similarly, the cytoskeleton of platelets is also dysfunctional. Virtually all patients have significantly decreased platelet counts and size at the time of diagnosis. The resulting clinical findings can range from petechiae or purpura to severe bleeding such as intracranial hemorrhage, hematemesis, or hematochezia. In addition, autoimmune disorders (eg, eczema) occur in most patients with WAS. The treatment of WAS is hematopoietic stem cell transplantation.
Brain Mets
For patients with a single brain metastasis in a surgically accessible location and good performance status, surgical resection offers the best therapeutic option. This is typically followed by stereotactic radiosurgery (SRS) or whole brain radiation therapy (WBRT) to the tumor bed. SRS may be used as an alternate therapeutic option for patients who are not candidates for surgery, have a surgically inaccessible lesion, or smaller metastasis (<3 cm). For patients with multiple brain metastases or poor performance status, WBRT or supportive care is typically recommended (Choice E).
Ankylosing spondylitis
RV MI
Therefore, in addition to standard MI therapy, such patients (without pulmonary congestion) are typically treated with boluses of intravenous fluids (isotonic saline) to improve RV preload and facilitate left ventricular filling.

Female Puberty
Breast development (thelarche) is typically the first sign of puberty in girls and occurs at age 8-12 in response to rising estrogen levels. Pubic hair development (pubarche) usually follows thelarche but can occur first. The onset of menses (menarche) is expected around Tanner stage 4, approximately 2-2.5 years after initial breast bud development. The average age for menarche is 12.5; however, lack of menses is considered normal at age <15 if development of secondary sex characteristics has been appropriate. In the 6 months preceding menarche, girls experience a growth spurt, a peak in growth velocity.
Tits, pits, mits, lips (breast, hair, growth, menarche)
Digitalis EKG
Atrial tachycardia with AV block is the arrhythmia most specific for digitalis toxicity. Digitalis can increase ectopy in the atria or ventricles, which can lead to atrial tachycardia. Atrial tachycardia is distinguished from atrial flutter by its somewhat slower atrial rate (150-250 bpm as opposed to 250-350 bpm). P-waves are present, but may appear different from the p-waves normally seen when conduction originates in the SA node. In atrial tachycardia, the closer the ectopic focus is to the SA node, the closer the resemblance of its p-waves to normal p-waves originating from the SA node. In addition to causing ectopic rhythms, digitalis can also increase vagal tone and decrease conduction through the AV node, potentially causing AV block. Since it is rare for both ectopy and AV block to occur at the same time, when they do, the combination is fairly specific for digitalis toxicity.
MDMA
MDMA (3,4-methylenedioxy-methamphetamine), also known as Ecstasy or Molly, is a synthetic amphetamine with mild hallucinogenic properties. It causes an increase in synaptic norepinephrine, dopamine, and serotonin. Neurotoxicity may develop with long-term use.
MDMA is often used by college students during parties to cause euphoria and increase sociability, empathy, and sexual desire. Intoxication may manifest as:
Amphetamine toxicity: Hypertension, tachycardia, and hyperthermia
Serotonin toxicity: Serotonin syndrome (characterized by autonomic dysregulation, high fever, altered mental status, neuromuscular irritability, and seizures) and hyponatremia (due to drug-induced inappropiate antidiuretic hormone secretion as well as excessive water intake to reduce hyperthermia)
Coma and death can result. As in this patient, combining MDMA with other serotonergic drugs (eg, serotonergic antidepressants) further increases the risk of serotonin syndrome. Illicit synthetic amphetamines and analogs (such as MDMA and bath salts) may or may not show up as amphetamines in routine urine toxicology screens.
Lyme Disease
Nl: doxycycline
Pregnant/lactating women: amoxicillin
Kids: amoxicillin
Anticholinergic
Symptoms include hallucinations/delirium, hyperthermia, tachycardia, nonreactive mydriasis, and dry, red skin ("mad as a hatter, hot as a hare, blind as a bat, dry as a bone, and red as a beet").
Methemoglobinemia
Clinical presentation of methemoglobinemia
History
Exposure to oxidizing substances (eg, dapsone, nitrites, local/topical anesthetic)
Clinical examination
Cyanosis Pulse oximetry saturation 85% Dark chocolate-colored blood
Laboratory findings
Saturation gap (>5% difference between oxygen saturation on pulse oximetry & ABG) Normal PaO2
ABG = arterial blood gas.
Methemoglobinemia is most commonly acquired after excessive exposure to an oxidizing agent (eg, dapsone, nitrites, local/topical anesthetics such as benzocaine/lidocaine). Methemoglobin is a form of hemoglobin in which 1 of the 4 iron molecules is oxidized to the ferric (Fe3+) rather than the normal ferrous (Fe2+) state. The ferric state has a decreased affinity for oxygen, but the remaining 3 ferrous heme sites have an increased oxygen affinity, which leads to decreased oxygen delivery to peripheral tissues.
Patients typically have cyanosis and dark chocolate-colored blood. Standard pulse oximetry readings are low (85%) due to the absorption spectrum of methemoglobin and do not represent the true oxygen saturation. Due to the poor oxygen affinity of methemoglobin, the administration of supplemental oxygen does not improve cyanosis, blood color, or pulse oximetry readings. Because arterial blood gas testing analyzes unbound arterial oxygen (as opposed to hemoglobin-bound oxygen), the PaO2 is normal and overestimates the degree of true oxygen saturation. With severe cases of methemoglobinemia, the decreased oxygen delivery can result in altered mental status, seizures, and death.
Treatment: Methylene blue acts as an electron acceptor for NADPH and is reduced to leucomethylene blue, which in turn reduces methemoglobin back to hemoglobin.
Serum sickness like
Serum sickness-like reaction
Etiology
Immune complex formation Antibiotics (beta-lactam, sulfa) Acute hepatitis B
Clinical features
Symptoms 1-2 weeks after exposure Fever, skin rash, polyarthralgia
Treatment
Remove/avoid offending agent Supportive care Steroids or plasmapheresis if severe
This child's symptoms (fever, urticaria, and joint pain), which began after 1 week of penicillin therapy, are concerning for a serum sickness-like reaction. A serum sickness-like reaction is a type III hypersensitivity reaction that occurs 1-2 weeks after administration of β-lactams (eg, penicillin, amoxicillin, cefaclor) or trimethoprim-sulfamethoxazole. Classic manifestations include fever, urticaria, and polyarthralgia with no mucosal involvement. The patient typically appears ill.
Laboratory findings that support the diagnosis of serum sickness-like reaction include nonspecific hypocomplementemia and elevated inflammatory markers (erythrocyte sedimentation rate, C-reactive protein), which are consistent with any type III hypersensitivity reaction. Removal of the offending agent is generally sufficient to relieve symptoms within 48 hours. More severe cases may require glucocorticoid therapy. Although serum sickness-like reaction is not a true allergy, the offending agent should be avoided in the future to prevent recurrence.

Jarich

This patient with primary syphilis (chancre) received a dose of penicillin G last night and now has the Jarisch-Herxheimer reaction. This reaction is seen primarily in patients with early syphilis treated with antibiotic medication. The rapid destruction of spirochetes causes an acute febrile illness, typically within 12 hours of treatment. Symptoms include headache, myalgias, rigors, sweating, hypotension, and worsened syphilitic rash (diffuse, macular, including palms and soles). Manifestations are usually self-limited and resolve spontaneously within 48 hours.
The Jarisch-Herxheimer reaction can also occur after the treatment of other spirochetes (eg, Borrelia burgdorferi) and atypical organisms (eg, Bartonella).
ENT Cancer
Squamous cell carcinoma of the mucosa of the head and neck is common in people with a significant history of alcohol and tobacco use (as in this patient). The first manifestation may be a palpable cervical lymph node. The best initial test is panendoscopy (triple endoscopy = esophagoscopy, bronchoscopy, laryngoscopy) to detect the primary tumor.
Panendoscopy is typically followed by a biopsy when a primary tumor is detected. This establishes a histologic diagnosis, which is essential for determining the proper management, as well as prognosis of the disease. The treatment of head and neck cancer is dependent on the stage, grade and histology of the tumor. The various treatment options include radical neck dissection, tumor resection, platinum-based chemotherapy, radiotherapy and palliative management.
Livedo Reticularis

Patients with risk factors for aortic atherosclerosis (eg, hypercholesterolemia, diabetes, peripheral vascular disease) who undergo cardiac catheterization or a vascular procedure are at increased risk for cholesterol emboli as a result of vascular manipulation. These emboli can occlude blood vessels and cause the following:
Skin manifestations: Livedo reticularis (reticulated, mottled, discolored skin), blue toe syndrome
Kidney manifestations: Acute kidney injury
Gastrointestinal manifestations: Pancreatitis, mesenteric ischemia
case: 67 yo man s/p elective coronary angiography present with N/V, abdominal pain, livedo reticularis, elevated lipase
Septic Abortion

This patient's presentation is consistent with a septic abortion, which typically presents with fever; lower abdominal pain; heavy vaginal bleeding; and a malodorous, purulent vaginal discharge. It can occur as a complication of any type of abortion but most frequently follows an unsterile and/or incomplete procedure for an elective abortion. Findings of a purulent discharge and enlarged, boggy, tender uterus on pelvic examination and an ultrasound showing intrauterine echogenic material with blood flow are consistent with inflammation and infection from retained products of conception.
Although the infection usually remains confined to the placental tissue of the retained products of conception, if untreated or observed (Choice D) it can spread into the uterine myometrium and can cause widespread infection. Due to these potential complications, a septic abortion is a medical emergency that requires prompt treatment to prevent progression to peritonitis, septic shock, and death. Treatment includes broad-spectrum antibiotics and uterine evacuation with suction curettage.
Statin
ASCVD: pts with cardiovascular disease, chronic renal failure, DM, or LDL > 190
no ASCVD: start statin when 10 year risk >7.5%
Restless leg

SCC vs BCC
bcc: upper lip
scc: lower lip
HAND
HIV-associated neurocognitive disorders
Manifestations
Impaired memory & attention/concentration Personality & behavior changes Motor symptoms (eg, ataxia, slowed movement)
Severity
Asymptomatic neurocognitive impairment Mild neurocognitive disorder HIV-associated dementia
Risk factors
Long-standing HIV disease Age >50 CD4 count <200/mm3
Diagnosis
Clinical presentation Neuropsychological testing
This patient has personality changes, forgetfulness, and signs of impaired neurocognitive function. Given his long-standing HIV disease, this presentation is most likely due to HIV-associated neurocognitive disorder (HAND). HAND is characterized by a chronic decline in multiple cognitive domains (eg, memory, attention, calculation, executive function). Mood and behavior disturbances are common. The diagnosis is based primarily on clinical features and neuropsychological testing, but MRI may also be helpful and shows a diffuse increase in intensity in the white matter.
HAND is due to replication of HIV in the central nervous system and has been associated with a broad range of deficits from asymptomatic impairments noted only on neuropsychological testing to severe dementia. The incidence of HIV dementia has declined with widespread use of highly active antiretroviral therapy, but less severe syndromes are common and may affect up to 69% of patients with chronic HIV. The risk increases with duration of HIV infection and is greatest in patients age >50 and with CD4 counts <200/mm3.
Vitamin D Deficiency

This infant's examination findings of costochondral joint hypertrophy ("rachitic rosary"), genu varum (femoral and tibial bowing), large anterior fontanel, and craniotabes are consistent with rickets. Nutritional rickets is caused by deficiency of vitamin D or calcium, with vitamin D deficiency being more common. The primary source of vitamin D is sunlight. People with dark skin pigmentation are at increased risk of vitamin D deficiency because melanin is a natural sunblock and prevents ultraviolet rays from reaching the skin for vitamin D synthesis. However, infants of all ethnicities are typically shielded from direct sunlight due to the risk of sunburn and skin cancer, making dietary intake the chief source of vitamin D. Although breast milk is the gold standard of nutrition for children age <1 year, breast milk alone does not have adequate vitamin D. Homemade baby food is also inadequate. Therefore, infants who do not ingest fortified baby food or formula should receive vitamin D supplementation of 400 IU daily to prevent rickets.
Clinical manifestations typically appear after several months of deficiency. X-ray findings include genu varum (blue arrows) in weight-bearing children, enlargement of the costochondral joints, and metaphyseal cupping and fraying. Treatment consists of vitamin D repletion with 1000-2000 IU daily.



NRDS
The most important risk factor for RDS is prematurity; other factors that increase RDS risk include male sex, perinatal asphyxia, maternal diabetes, and cesarean section without labor. Maternal diabetes increases the incidence of RDS by delaying the maturation of pulmonary surfactant production. Maternal hyperglycemia causes fetal hyperglycemia, which in turn triggers fetal hyperinsulinism. High levels of circulating insulin antagonize cortisol and block the maturation of sphingomyelin, a vital component of surfactant.
anything increases neonatal stress is good for lungs (PROM, growth restriction, maternal hyptertension, vaginal delivery)
Succinylcholine
This patient has experienced an extensive skeletal muscle crush injury, which places him at risk for hyperkalemia due to skeletal muscle cell lysis (rhabdomyolysis). In addition, skeletal muscle injury leads to upregulation of postsynaptic acetylcholine receptors, which can result in massive efflux of potassium following administration of succinylcholine. Other relevant conditions that cause upregulation of acetylcholine receptors include burn injury, disuse muscle atrophy, and denervation (eg, stroke, Guillain-Barré syndrome, critical illness polyneuropathy)
Halothane can lead to acute liver failure due to production of hepatoxic intermediary compounds; therefore, it is now rarely used. Adult women are at greatest risk of developing halothane-associated liver toxicity.
Etomidate inhibits 11β-hydroxylase and can lead to adrenal insufficiency. The elderly and patients with critical illness (eg, sepsis) are typically susceptible.
Nitrous oxide inactivates vitamin B12, leading to inhibition of methionine synthase activity; subsequent neurotoxicity (eg, peripheral neuropathy) can result in patients with preexisting vitamin B12 deficiency.
Severe hypotension due to myocardial depression is a common adverse effect of propofol. Therefore, propofol should be avoided or used with extreme caution in patients with ventricular systolic dysfunction.
Kawasaki

Kawasaki disease (KD), also known as mucocutaneous lymph node syndrome, is a vasculitis characterized by fever ≥5 days in addition to ≥4 of the following mucocutaneous findings:
Conjunctivitis: Bilateral, nonexudative, spares the limbus
Oral mucosal changes: Erythema, fissured lips, "strawberry tongue"
Rash
Extremity changes: Erythema, edema, desquamation of the hands and feet
Cervical lymphadenopathy: >1.5 cm node
Irritability, as seen in this patient, is also a common feature.
Although KD is self-limited, treatment with intravenous immunoglobulin should be started within 10 days of fever onset to help prevent coronary artery aneurysms. Aspirin, although typically avoided in pediatric patients due to the risk of Reye syndrome, is also indicated for all patients with KD as it has anti-inflammatory and antiplatelet effects. To assess for cardiac complications, echocardiography should be performed on suspicion of diagnosis and repeated after therapy to assess for change.
Friedreich Ataxia
Friedreich ataxia
Genetics
Autosomal recessive Loss-of-function, trinucleotide repeat (GAA) in frataxin gene
Clinical features
Neurologic deficits Cerebellar ataxia Dysarthria Loss of vibration and/or position sense Absent deep tendon reflexes Hypertrophic cardiomyopathy Skeletal deformities (eg, scoliosis) Diabetes mellitus
Prognosis
Mean survival age 30-40 Mortality due to cardiac dysfunction (eg, arrhythmia, congestive heart failure)
Friedreich ataxia (FA) classically presents as progressive gait ataxia and dysarthria in adolescents or young adults. FA is an autosomal recessive disorder caused by a trinucleotide repeat (GAA) expansion that results in a loss-of-function mutation in the frataxin gene. Neurologic manifestations (eg, ataxia, dysarthria, loss of vibration/position sense) result from degeneration of the spinal tracts (ie, spinocerebellar tracts, posterior columns). Other clinical features include hypertrophic cardiomyopathy, diabetes mellitus, and skeletal deformities (eg, scoliosis).
Treatment typically involves multidisciplinary supportive care and monitoring for complications; there is no specific disease-modifying therapy. After disease onset, survival rarely exceeds 20 years. The most common cause of death is cardiac dysfunction related to cardiomyopathy, typically a fatal arrhythmia or congestive heart failure.
Friedreich ataxia
Reye Syndrome
Clinical features of hepatic dysfunction include nausea, vomiting, and hepatomegaly. Laboratory derangements include elevated transaminases, coagulopathy (prolonged PT, INR, and PTT), and hyperammonemia. Excess ammonia is neurotoxic and causes cerebral edema and encephalopathy (eg, mental status changes).
A diagnosis of Reye syndrome is rare but potentially life-threatening (30% mortality). The presence of microvesicular steatosis on liver biopsy in the context of acute hepatic encephalopathy is consistent with Reye syndrome. Parents should be reminded that aspirin is generally contraindicated in children, except in the treatment of Kawasaki disease and rheumatologic diseases (eg, juvenile idiopathic arthritis).
Treatment: supportive
Homocysteine DVT
This patient has deep venous thrombosis (DVT) in the setting of increased homocysteine levels. Homocysteine is a highly reactive amino acid. Increased levels predispose to venous thrombosis as well as atherosclerosis, presumably due to a combination of direct vascular damage, activation of clotting mechanisms, and inhibition of antithrombotic pathways. Thus, this patient's DVT treatment should include an attempt to correct her homocysteine level.
Homocysteine can be metabolized to cysteine or methylated to form methionine. If either of these pathways is disrupted by an enzyme or cofactor deficiency, elevated homocysteine levels result. The homocysteine to cysteine pathway is catalyzed by cystathionine β-synthase (CBS) using the cofactor pyridoxine (B6). The homocysteine to methionine pathway is catalyzed by methylenetetrahydrofolate reductase (MTHFR) and methionine synthase (MS), with folate and cobalamin (B12) as essential cofactors (see figure).
Independent of the underlying cause, homocysteine levels can usually be normalized by administration of pyridoxine (B6) and folate. Vitamin B12 should be added if a B12 deficiency is documented. Although this treatment does correct homocysteine levels, it is still unclear whether it reverses hypercoagulability.

CF peumonia

Patients with CF are at high risk of infection from unusual and resistant bacteria, viruses, and fungi due to exposure to multiple antibiotic courses. The most common pathogen isolated from sputum cultures in infants and young children is Staphylococcus aureus, a gram-positive coccus that grows in clusters. S aureus colonization decreases with age but remains a significant source of disease in adults with CF.
Colonization and infection with Pseudomonas aeruginosa can occur as early as infancy and is the most common cause of CF-related pneumonia in adults. Given its association with a precipitous decline of pulmonary function and increased risk of death, Pseudomonas should be treated for during initial management but is not the most common pathogen in children.
Paget's
Typical findings on imaging include cortical thickening and osteolytic or mixed lytic/sclerotic lesions on x-ray as well as focally increased radiotracer uptake on bone scan. Also increased alkaline phosphatase activity.
Patients with Paget disease can develop symptoms due to focal enlargement, weakness, or fracture of bone. Bowing of long bones, bone pain, and arthritis in adjacent joints are common. Involvement of cranial bones may cause frontal bossing, increased hat size, headaches, and cranial nerve palsies. Hearing loss may occur due to enlargement of the temporal bone and encroachment on the cochlea.
Duodenal vs Jejunal


Intestinal atresia can occur anywhere along the gastrointestinal tract. Atresia of the jejunum or ileum is thought to occur due to a vascular accident in utero that causes necrosis and resorption of the fetal intestine, sealing off and leaving behind blind proximal and distal ends of intestine. Risk factors include poor fetal gut perfusion from maternal use of vasoconstrictive medications or drugs such as cocaine and tobacco. Some cases have been associated with meconium ileus/cystic fibrosis during which inspissated meconium causes a localized volvulus that results in ischemic necrosis. In contrast to duodenal atresia, jejunal and ileal atresia are not associated with chromosomal abnormalities.
The presence of the "triple bubble" sign and gasless colon on abdominal x-ray (above) reflects gas trapping in the stomach, duodenum, and jejunum. Treatment should be focused initially on resuscitation and stabilization of the patient, followed by surgical correction. The prognosis depends on the length of affected bowel as well as the patient's gestational age and birth weight.
Pulmonary nodules on Xray

Trachoma

This child's conjunctival injection, tarsal inflammation, and pale follicles are concerning for trachoma. Trachoma is due to Chlamydia trachomatis serotypes A, B, and C and is the leading cause of blindness worldwide. C trachomatis spreads effectively in crowded or unsanitary conditions. The active phase is most common in children and is characterized by follicular conjunctivitis and pannus (neovascularization) formation in the cornea. There is often a concomitant nasopharyngeal infection (eg, rhinorrhea, pharyngitis). Repeated or chronic infection leads to scarring of the eyelids and inversion of the eyelashes (trichiasis). Over time, the lashes rub on the eye and cause ulcerations and blindness (cicatricial trachoma).
The diagnosis can be made clinically by examination of the tarsal conjunctivae. C trachomatis may be visible by Giemsa stain examination of conjunctival scrapings. Oral azithromycin is effective against C trachomatis; in general, the entire region (eg, village, refugee camp) should be treated simultaneously. For individuals with trichiasis, eyelid surgery is needed to preserve vision.
Interstitial Cystitis
Interstitial cystitis (bladder pain syndrome)
Epidemiology
More common in women Associated with psychiatric & pain disorders (eg, fibromyalgia)
Clinical presentation
Bladder pain with filling, relief with voiding ↑ Urinary frequency, urgency Dyspareunia
Diagnosis
Bladder pain with no other cause for ≥6 weeks Normal urinalysis
Treatment
Not curative, focus is on improving quality of life Behavioral modification, avoidance of triggers, physical therapy Amitriptyline, pentosan polysulfate sodium Analgesics for acute exacerbations
Interstitial cystitis (also known as painful bladder syndrome) is a chronic, painful bladder condition of uncertain etiology. The pelvic pain in interstitial cystitis is classically exacerbated by bladder filling and relieved by voiding. The onset of the symptoms is typically gradual, and the symptoms worsen over a period of months. Other characteristic symptoms include urinary urgency and frequency, and chronic pelvic pain. The pain can be exacerbated by exercise, sexual intercourse (dyspareunia), and alcohol consumption.
The diagnosis of interstitial cystitis is primarily clinical. Urinalysis is obtained to exclude other causes of bladder pain (eg, urinary tract infection, sexually transmitted disease, cancer); results are normal in interstitial cystitis. Treatment is palliative and includes trigger avoidance, amitriptyline, and analgesics for pain flares.
TB
HIV-positive patients
Recent contacts of known TB case
Nodular or fibrotic changes on chest x-ray consistent with previously healed TB
Organ transplant recipients & other immunosuppressed patients
Bacterial Meningitis
Bacterial meningitis
Risk group
Common organisms
Empiric antibiotics
Age 2-50
Streptococcus pneumoniae, Neisseria meningitidis
Vancomycin + 3rd-generation cephalosporin
Age >50
S pneumoniae, N meningitidis, Listeria
Vancomycin + ampicillin + 3rd-generation cephalosporin
Immunocompromised
S pneumoniae, N meningitidis, Listeria,gram-negative rods
Vancomycin + ampicillin + cefepime
Neurosurgery/penetrating skull trauma
Gram-negative rods, MRSA, coagulase-negative staphylococci
Vancomycin + cefepime
3rd-generation cephalosporins: ceftriaxone or cefotaxime
Alternatives to cefepime: ceftazidime or meropenem
Alternative to ampicillin: trimethoprim-sulfamethizole for Listeria
Vanc: for cephalosporin resistant pneumococci
Zonisamide CI
nephrolithiasis
Stroke

This patient most likely has an anterior cerebral artery (ACA) stroke. This condition is characterized by contralateral motor and/or sensory deficits, which are more pronounced in the lower limb than in the upper limb (as seen in this patient). Other features may include urinary incontinence (from damage to the cortical micturition centers of the mesial frontal lobe), gait dyspraxia, primitive reflexes (eg, grasp, sucking), abulia, and emotional disturbances.
A posterior cerebral artery stroke is characterized by homonymous hemianopia, alexia without agraphia (dominant hemisphere), visual hallucinations (calcarine cortex), sensory symptoms (thalamus), third nerve palsy with paresis of vertical and horizontal eye movements, and contralateral motor deficits (cerebral peduncle, midbrain).
Testosterone usage
This patient's increased aggression, accelerated male pattern baldness, and gynecomastia are concerning for anabolic (androgenic) steroid use. Anabolic steroids (eg, testosterone, trenbolone, boldenone, stanozolol, nandrolone) are popular among young people and athletes looking to improve their physical appearance and performance.
Anabolic steroid side effects include impaired endogenous testicular function and decreased testicular size and sperm count. Hepatic dysfunction may occur, and patients can develop erythrocytosis due to androgen-stimulated erythropoiesis. HDL levels decrease, and high doses may even cause cardiac dysfunction. Gynecomastia can develop when excess testosterone is converted to estradiol, leading to breast enlargement. Skin changes include acne and premature or accelerated male pattern baldness. Psychiatric effects include aggression and mood disturbances that are often complicated by concurrent alcohol use.
Lithium
Medications that can increase lithium levels include Thiazides, ACE inhibitors, nonsteroidal anti-inflammatory drugs, tetracyclines, and metronidazole. Can also increase with volume depletion. Medications that can decrease serum lithium levels include theophylline and potassium-sparing diuretics (eg, spironolactone).
HIDA
The hepatobiliary iminodiacetic acid (HIDA) scan uses a nuclear tracer that is excreted in bile. Failure to visualize the tracer in the gallbladder suggests obstruction. HIDA can be used for evaluating cholecystitis in patients with indeterminate ultrasound findings.
Endoscopic retrograde cholangiopancreatography (ERCP) is recommended in patients with gallstone pancreatitis who have cholangitis, visible common bile duct dilation/obstruction, or increasing liver enzyme levels. ERCP allows for cannulation and sphincterotomy in an attempt to relieve the obstruction.Copyright (c) UWorld, Please do not save, print, cut, copy or paste anything while a test is active.
Double Duct Sign
pancreatic cancer, enlarged common hepatic and pancreatic duct

Courvoisier sign
nontender enlarged gallbladder, sign of pancreatic cancer
Down syndrome

LCP

This patient has Legg-Calvé-Perthes (LCP) disease, or idiopathic osteonecrosis(avascular necrosis) of the femoral epiphysis. This condition most commonly affects boys age 3-12, with a peak incidence between age 5 and 7.
Typical presentation includes chronic, progressive leg pain and/or a limp. The pain is often worse with activity and may be localized to the hip or referred to the groin, thigh, or knee. Physical examination may reveal limited range of motion, particularly internal rotation and abduction, of the hip and atrophy of the proximal thigh muscle. Although x-rays early in LCP disease may be normal, subacute or chronic symptoms usually indicate a flattened and fragmented femoral head, such as in this patient. The alternating regions of lucency and density reflect replacement of necrotic bone by new bone.
Patients are made non–weight bearing and are managed conservatively with bracing or splinting. Surgery may be indicated in cases in which the femoral head is not well contained within the acetabulum.
BPH

This patient's presentation is consistent with benign prostatic hyperplasia (BPH). BPH typically affects men age >50 and is the most common cause of lower urinary tract symptoms (eg, urinary frequency, urgency, weak stream, nocturia) in these patients. Prostate cancer (which is associated with elevated prostate-specific antigen levels) can also cause lower urinary tract symptoms. However, prostate cancer more often involves the periphery of the gland and presents with firm asymmetric or nodular enlargement, whereas BPH involves the center (transitional zone) and presents with smooth, nonindurated, symmetric enlargement.
The preferred initial treatment for uncomplicated BPH includes alpha-1 blockers(eg, terazosin, tamsulosin), which can provide rapid relief of symptoms by relaxing bladder neck and prostatic smooth muscle. 5-alpha-reductase inhibitors (eg, finasteride) can be used in addition to alpha blockers for patients with persistent symptoms or as an alternate therapy for those who do not tolerate alpha blockers (eg, hypotension). However, they act by reducing prostate size and have a much slower onset of action (ie, months) (Choice A).
Study design

A factorial design (as shown above) involves 2 or more experimental interventions, each with 2 or more variables that are studied independently.
Compartment
compartment syndrome
Unilateral Hip Pain
Trochanteric bursitis is inflammation of the bursa surrounding the insertion of the gluteus medius onto the femur’s greater trochanter. Excessive frictional forces secondary to overuse, trauma, joint crystals, or infection are responsible. Patients with this condition complain of hip pain when pressure is applied (as when sleeping) and with external rotation or resisted abduction.
Hip osteoarthritis causes pain localized deep within the joint (in contrast to the superficial tenderness here) that may be referred to the inguinal area or rarely to the knee. Hip osteoarthritis is uncommon before the age of 50. Classically, internal rotation of the hip worsens this pain.
Urethra Injury

This patient's adducted and internally rotated right lower extremity (suggestive of acetabular fracture with posterior hip dislocation), pain in the lower abdomen and groin, and bruising along the scrotum and perineum are consistent with pelvic fracture. Due to the length and positioning of the male urethra, men with pelvic fractures are at significant risk for posterior urethral injury (PUI). Abrupt upward shifting of the bladder and prostate can lead to urethral tearing, which most commonly affects the membranous urethra at the bulbomembranous junction(dividing point between the anterior and posterior urethra). Findings consistent with PUI include blood at the urethral meatus, inability to void, perineal or scrotal hematoma, and a high-riding prostate on digital rectal examination.
In patients with suspected urethral injury, a retrograde urethrogram should be performed. This diagnostic test involves an x-ray of the lower genitourinary tract obtained during the injection of radiopaque contrast into the urethra. A normal study demonstrates contrast entering the bladder uninterrupted. Extravasation of contrast from the urethra or inability of contrast to reach the bladder is diagnostic of urethral injury.
CF
thin microcolon from underdevelopment
SSSS
superficial flaccid blister
located predominantly in flexural areas exposed to mechanical pressure (eg, axillae, groin). Although perioral crusting can occur, mucosal surfaces are typically spared. (TEN has +mucous membrane)
Gentle pressure on the skin surface causes detachment of a superficial layer of skin (ie, Nikolsky sign), and epidermal shedding exposes underlying erythematous skin with a scalded appearance.
Asymptomatic Bacteriuria
First-line antibiotics include cephalexin, amoxicillin-clavulanate, and nitrofurantoin.
Thyroid Lymphoma
Thyroid lymphoma is uncommon, but the incidence is approximately 60 times greater in patients with preexisting chronic lymphocytic (Hashimoto) thyroiditis (ie, chronic hypothyroidism, positive antithyroid peroxidase antibody). As seen in this patient, the typical presentation of thyroid lymphoma includes a rapidly enlarging, firm goiter associated with compressive symptoms (eg, dysphagia, hoarseness). As with other lymphomas, patients may have systemic B symptoms(eg, fever, night sweats, weight loss).
Mild pain and tenderness may be present, and the gland is frequently fixed to the surrounding structures and does not move up when swallowing. Retrosternal extension of the tumor is common and can result in venous compression with distended neck veins and facial plethora; raising the arms causes compression of the subclavian (and right internal jugular) vein between the clavicles and the enlarged thyroid, leading to more prominent venous distension and facial redness (Pemberton sign).
Inflammatory markers (eg, erythrocyte sedimentation rate) can be elevated but are nonspecific. CT imaging typically reveals diffuse enlargement of the thyroid around the trachea (doughnut sign). Core or excisional biopsy may be required, and flow cytometry can confirm monoclonal lymphoma cells.
Thyroid lymphoma
Malaria
.,
Hemophilia
Hemophilic arthropathy refers to joint damage caused by intra-articular bleeding. Hemosiderin deposition within the joint triggers synovial inflammation, which leads to fibrosis and destruction of cartilage and bone. Chronic, worsening joint pain and swelling are accompanied by limited mobility on examination.
Pseudotumor Cerebri
Several medications, including growth hormone, tetracyclines (eg, minocycline, doxycycline), and excessive vitamin A and its derivatives (eg, isotretinoin, all-trans-retinoic acid) can cause IIH. Withdrawal of the offending medication usually leads to resolution of symptoms.
Patellofemoral syndrome


This patient, a young woman with chronic anterior knee pain that is worse with climbing stairs, shows typical features of patellofemoral syndrome (PFS), a very common cause of chronic knee pain. Women are affected much more frequently than men. Risk factors include overuse, malalignment, and trauma, although overuse during training is probably most common.
The diagnosis is often challenging to confirm and is based primarily on history and examination findings. The patellofemoral compression test (pain elicited by extending the knee while compressing the patella) and reproduction of pain with squatting are highly suggestive. Tests such as x-ray of the knee and magnetic resonance imaging are usually normal and are generally needed only if the diagnosis is in doubt or the patient fails to improve as expected.
Management of PFS is primarily mechanical - exercises to stretch and strengthen the thigh muscles and avoiding activities that aggravate the pain. Nonsteroidal anti-inflammatory drugs are often prescribed but frequently not helpful. Persistence is required on the part of the patient as resolution of symptoms may often take weeks to months.
Osgood Schlatter

Tenderness at the tibial tubercle is a typical finding for Osgood-Schlatter disease. This condition is caused by chronic/repetitive strain at the insertion of the patellar tendon on the tibial tubercle and is seen in pre-adolescent and adolescent patients undergoing rapid growth spurts. Like PFS, Osgood-Schlatter disease can cause anterior knee pain that is worse with squatting; however, it would not be seen in adult patients.
Parapneumonic effusion
Effusions divided into transudative and exudative
Parapneumonic effusions
Uncomplicated
Complicated
Etiology
Sterile exudate in pleural space
Bacterial invasion of pleural space
Pleural fluid analysis
pH ≥7.2 Glucose ≥60 mg/dL WBC ≤50,000/mm3
pH Glucose less than 60 mg/dL WBC >50,000/mm3
Pleural fluid Gram stain & culture
Negative
Negative*
Treatment
Antibiotics
Antibiotics + drainage
Pleural fluid glucose <60 mg/dL is usually due to rheumatoid pleurisy, complicated parapneumonic effusion or empyema, malignant effusion, tuberculous pleurisy, lupus pleuritis, or esophageal rupture. (Pleural glucose <30 mg/dL in particular suggests an empyema or rheumatic effusion.) Glucose concentration in empyema is decreased due to the high metabolic activity of leukocytes (and/or bacteria) in the fluid.
Normal pleural fluid pH is approximately 7.60. Transudative fluid is usually due to systemic factors (eg, increased hydrostatic pressure or hypoalbuminemia) and has a pleural fluid pH of 7.4-7.55. Exudate is usually due to inflammation with a pleural fluid pH of 7.30-7.45. Pleural fluid pH <7.30 (with normal arterial pH and low pleural glucose) is usually due to increased acid production by pleural fluid cells and bacteria (eg, empyema) or decreased hydrogen ion efflux from the pleural space (eg, pleuritis, tumor, pleural fibrosis).
abscess: cavity with air fluid


Neuroblastoma
Neuroblastoma
Pathogenesis
Neural crest origin Involves adrenal medulla, sympathetic chain
Clinical features
Median age Abdominal mass Periorbital ecchymoses (orbital metastases) Spinal cord compression from epidural invasion ("dumbbell tumor”) Opsoclonus-myoclonus syndrome
Diagnostic findings
Elevated catecholamine metabolites Small, round blue cells on histology N-myc gene amplification
This patient has Horner syndrome in the setting of a cervical paravertebral mass, findings suspicious for neuroblastoma. Neuroblastoma is the most common extracranial solid tumor of childhood, with a median age <2. The tumor arises from neural crest cells, which are precursors to the sympathetic ganglia and adrenal medulla, the latter of which is the most common site of neuroblastoma.
Tumor involvement of the cervical paravertebral sympathetic chain can lead to ipsilateral Horner syndrome (ie, ptosis, miosis, anhidrosis). Although sweating is often difficult to appreciate in young children, absent facial flushing (ie, "harlequin" sign) can be observed in anhidrotic areas, as seen in this patient.
Urine and serum catecholamines (vanillylmandelic acid and homovanillic acid) are elevated in the majority of patients; tissue biopsy is required for definitive diagnosis.
AIDS diarrhea

Cancer Pain

Last updated
Was this helpful?
